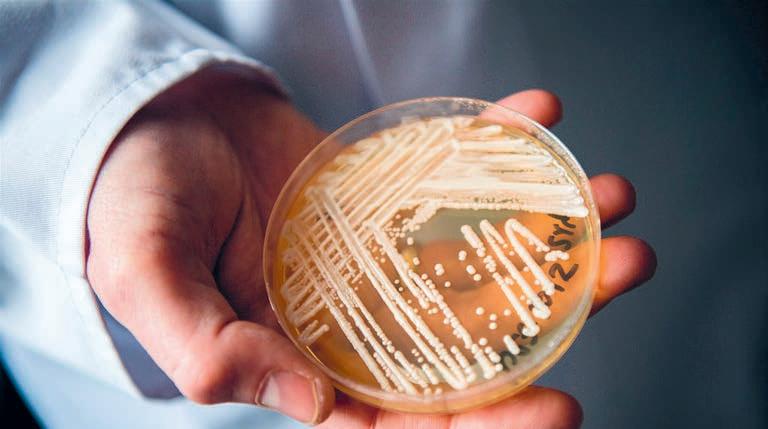

Zutphen
Onbetaalbaar...
gratis bij 35.290
Jeroen wint mooi bedrag
ZUTPHEN - Jeroen uit Zutphen speelde liefst 64.000 euro bij elkaar in het televisieprogramma VriendenLoterij Miljonairs. Zaterdagavond was bij RTL4 te zien hoe hij dit bedrag won. De geluksvogel kwam terecht op de spannendste stoel van Nederland tegenover presentator Robert ten Brink. Jeroen wil met zijn familie graag gaan reizen, bijvoorbeeld naar Australië of Nieuw-Zeeland.
Muziek in de synagoge
ZUTPHEN - Zondag 10 maart klinken in de Synagoge Zutphen, Dieserstraat 11, vanaf 15.00 uur Klezmer-, Jiddische- en Hebreeuwse liederen. Deze worden ten gehore gebracht door Baruch Chauskin & Duo NIHZ. Entree is gratis, met een collecte na afloop. Vrolijkheid, melancholie, passie, herinnering en het typisch Jiddische wisselen elkaar af en de musici nemen het publiek mee op een bijzondere Joods-muzikale reis. Tijdens, voor en na het concert is er een kleine tentoonstelling te zien over het bijzondere verhaal van Johnny & Jones, twee Joodse musici van wie tijdens het concert ook muziek gespeeld wordt. Tevens zijn Judaicakunstwerken te zien van de Joodse kunstenares Orna Baina. Info: www.question filosofie.nl. Toegangskaarten via sannavanelst@gmail.com
Kaarten voor Expeditie NEXT
ZUTPHEN - Voor allerlei wetenschappelijke proefjes, spellen en tours moet je in de komende meivakantie in Zutphen zijn. Expeditie NEXT, het nationale wetenschapsfestival voor kinderen, vindt op woensdag 1 mei plaats en kaarten zijn vanaf nu te koop via expeditienext.nl/tickets.

Wij
Van Rumund nieuwe burgemeester

BRUMMEN - Met ingang van 1 maart is Geert van Rumund (68 jaar, PvdA) waarnemend burgemeester van de gemeente Brummen. Dit voor een periode van minimaal één jaar.
Van Rumund kent de provincie Gelderland goed; zo was hij van 2005 tot en met 2021 burgemeester in de gemeente Wageningen. Daarvoor was hij 7,5 jaar wethouder in de gemeente Nijmegen, met
Koning naar Zutphen
ZUTPHEN - Koning WillemAlexander brengt dinsdag 12 maart een werkbezoek aan Stichting Urgente Noden (SUN) Nederland vanwege haar 110-jarig bestaan. Het werkbezoek vindt plaats in Zutphen, waar recent een nieuw SUN-noodhulpbureau is opgericht.
De koning spreekt met diverse mensen over het werk van SUN Nederland,
Tandartspraktijk
Paardenwal
Voor
het belang van noodhulp en over de impact van de gift of renteloze lening op het leven van mensen die deze hebben ontvangen op het moment dat zij urgente nood hadden. Daarnaast worden de eerste resultaten van het wetenschappelijk onderzoek naar het effect van SUN-noodhulp toegelicht.
Lees verder op pagina 7.
als portefeuille onder andere zorg en welzijn, sociale zaken en educatie. Geert van Rumund is in de gemeente Brummen de opvolger van Alex van Hedel, die na tien jaar
burgemeesterschap eind februari de ambtsketen neerlegde. De nieuwe burgervader heeft er veel zin in: “Ik ben zeer gemotiveerd om mij gedurende mijn waarneming samen met het bestuur
van Brummen onder andere te richten op het tot stand komen van een toekomstvisie voor de gemeente, het verbeteren van de financiële positie en het versterken van de ambtelijke organisatie.”
Vakantie voor Berlijnse jeugd
ZUTPHEN - Pax Kinderhulp zoekt voor de periode van 23 maart tot 5 april en van 20 juli tot 9 augustus nog vakantiegezinnen voor Berlijnse kinderen van 5 tot 12 jaar. De kinderen komen vooral uit ontwrichte gezinnen of kindertehuizen.
Voor armoede is er veel aandacht in Berlijn, maar voor de sociale gevolgen van die armoede is veel
minder belangstelling. Armoede isoleert mensen, maakt het mensen onmogelijk om nog langer mee te doen in de maatschappij. Armoede maakt het voor ouders moeilijk om hun kinderen de gewenste mogelijkheden te bieden om zich te ontplooien. Daarom regelt Pax Kinderhulp vakanties voor die kinde ren. Samen met Berlijnse hulpinstanties en de steun







van gastouders kan Pax Kinderhulp deze kinderen een onvergetelijke vakantie in Nederland bezorgen. Ook voor het vakantiegezin is het een belevenis om te zien wat het voor deze kinderen betekent om een beetje liefde en aandacht te krijgen.











.nl NIEUWSBLAD VOOR APELDOORN-DEVENTER-ZUTPHEN - OPLAGE CA. 154.340 EX. 48e JAARGANG NR. 10 - WOENSDAG 6 MAART 2024 Voor het meest lokale nieuw s
huishoudens
daarom
VERSTOPTE AFVOER OF RIOLERING?
Rioolreinigingsbedrijf B. Langenbach v.o.f.
of 06-55393920 www.langenbachvof.nl Jutlandsestraat 3, Zutphen Tel: 0575-517999 - www.kachelswk.nl Maart Actiemaand! www.sushibrothers.nl • Industrieweg 99h Zutphen • 0575-853031
BEL
055-5411660
Degen
3, Zutphen
jong en oud
declareren
zorgverzekering
tandheelkunde - parodontologie - implantaten - (klik)gebitten
Paulus Potterstraat 6 Zutphen tel. 06 - 16 459 367 tel. 085 - 773 37 52 Dikkertje Dap DE MOOISTE STOFFENZAAK VAN NEDERLAND! GRATIS PARKEREN STOFFENMARKT XXL LOCHEMSEWEG 3 - EPSE - javro.nl Ma 13.00-21.00, di. t/m vr. 9.00-18.00, za. 9.00-17.00 Meer weten over een krantenwijk bij All-Inn? Scan de qr-code of ga naar allinnbezorger.nl/playstation Maak kans op een Playstation 5 Bezorg bij jou in de buurt Bepaal je eigen werktijden Lekker buiten aan het werk Ook leuk als vakantiebaantje Op zoek naar een bijbaantje? Meld je snel aan voor een krantenwijk bij jou in de buurt!
bij uw
Algemene
www.tandartsdegen.nl 0575-545953 info@tandartsdegen.nl

GOED BEKEKEN
Eke Mannink is schrijver & voormalig stadsdichter van Zutphen. Vanuit het hart van de stad houdt ze wat ze ziet poëtisch tegen het licht. Want als je goed kijkt, zie je méér. Iedere week weer.
Prikwijn
We zijn op een onverwacht feestje. Onverwacht voor iedereen. ‘Eke!’ klonk een paar minuten geleden door de Kolenstraat. Ik draaide me om. Het silhouet van Mirjam van Biemen, een fles vasthoudend. ‘Ik heb een uitgever!’ Haar blijdschap echode tegen de gevels.
En nu zitten we binnen, in een kring rondom de tafel. Sigaretten her en der –’het lijken wel de jaren 50,’ zeg ik, ‘die lucht heb ik lang niet meer in mijn neus gehad’ –, in de fles bleek prikwijn te zitten.
Ik ken Mirjam vanaf het begin van het millennium. We werkten samen voor de KRO, een tijdje voor hetzelfde programma op radio 2: Dolce Vita. Zij maakte wekelijks een portret over de liefde, ik wandelde met mijn hond door het land en monteerde levensverhalen. Schilderijtjes van geluid waren het –we deden het allebei graag. Vorig jaar vierde Mirjam dat haar manuscript af was. Het is een boek over haar jeugd, een jeugd met een afwezige moeder. ‘Mama wil weg’ is de titel. Toen Mirjam acht was, stapte haar moeder uit het leven. Het laatste deel ervan had ze in een inrichting te Wassenaar doorgebracht. Dit weet ik uit een radiodocumentaire die Mirjam tien jaar geleden maakte. Ze deed onderzoek, en concludeerde: mijn moeder was niet gek.
Wat er aan de hand was, ontdekte Mirjam pas rond haar veertigste, toen ze eindelijk in de dagboekjes durfde te kijken die haar moeder had nagelaten bij haar dood: drie dikke kantoorboekjes en één blocnote, die haar
dochter op haar twintigste in bezit kreeg. Wat zeer waarschijnlijk tot de dood van haar moeder heeft geleid, beschrijft ze gedetailleerd in haar boek.
Daar is nu dus een uitgever voor, en niet de minste.
‘Proost!’ We klinken en drinken op deze mijlpaal.
Wanneer ik mijn buurvrouw vraag hoe zij haar dagen invult, giert Mirjam – Mirjam is goed in gieren, dat vind ik leuk aan haar – het uit. ‘Dat is een column, Eke!’ hamert ze in de lucht, in haar andere hand een glas, ‘Dat is een column!’ Wat blijkt? De buurvrouw werkte jaren bij een winkel in onze stad, tot het faliekant mis ging afgelopen oktober. Het is een schokkend verhaal, en ik vind meteen dat Mirjam gelijk heeft: daar zit een verhaal in. Dat verhaal heb ik inmiddels geschreven. Maar het mag nog niet in de krant. Er zijn te veel belangen mee gemoeid. En er speelt een juridische strijd.
‘Als dat geen column wordt, dan weet ik het niet meer,’ zegt Mirjam, terwijl ze naar de fles grijpt om een nieuwe ronde in te schenken.
‘Dan ga ik eerst maar eens praten met alle betrokkenen,’ zeg ik. ‘Om te weten hoe het zit. En laten we nog een keer proosten op je boek, want daarom zijn we hier verzameld.’ Daar is iedereen het mee eens. De gebelden, de van straat geplukten – allemaal heffen we onze glazen en we kijken verwachtingsvol naar de gastvrouw. Ze straalt. Weet je wat? Dáár gaat dit stukkie over.
VoetFlex Podotherapie combineert manueeltherapie en
ZUTPHEN - In Zutphen start een nieuwe praktijk voor podotherapie: VoetFlex. Niko Hartz, podotherapeut, zegt hierover: “De afgelopen acht jaar heb ik een unieke en beproefde methode toegepast bij sporters en wandelaars met pijnklachten in voet, knie, heup of onderrug. De meesten van de door mij behandelde patiënten zijn binnen zes weken na de eerste behandeling pijnvrij of de pijn is aanzienlijk afgenomen. Deze kennis wil ik graag toepassen in Zutphen en omgeving.”
De methode
Niko Hartz over de vrij unieke methode binnen podotherapieland: “Tijdens het onderzoek kijk ik naar het hele lichaam en zoek naar de achterliggende oorzaken. Dit zijn vaak blokkades in de gewrichten van voet en enkel. Ik pas manuele therapie toe om deze blokkades op te lossen. Patiënten kunnen hierdoor weer stabiel en goed hun voeten afwikkelen. Dit effect wordt versterkt door podotherapeutische zolen. Door deze aanpak verdwijnen pijnklachten snel en structureel.” Ook in het geval van Fasciitis Plantaris of hielspoor helpt deze aanpak goed. Hielspoor komt vaak voor bij wandelaars en sporters. Aanvullend geeft de podotherapeut oefeningen
correctiezolen

mee. Hierdoor verdwijnt de klacht vaak al binnen vijf à zes weken.
Pijn in onderrug vaak door geblokkeerde grote teen Bij mensen met een functioneel geblokkeerd grote-teengewricht komt pijn in de onderrug vaak voor. Onderrugpijn zit vaak op de hoogte van L4-L5. Een stijf grote-teengewricht tijdens het lopen, ook wel functionele hallux limitus genoemd, komt door een gewrichtsblokkade in enkel en/of voet. Deze laatste blokkade wordt gecompenseerd door het naar voren buigen van de rug tijdens de afzet van de grote teen van de grond, met als gevolg instabiliteit van de rug tussen L4-L5 en compressiedruk op de tussenwervelschijf aldaar.
Echt tijd voor de klant als helpende (plus) in de wijk
Vind je het belangrijk om écht een band met de klant op te bouwen? Dat kan als helpende (plus) in de wijk. Tijdens jouw dienst ga je naar 3 of 4 klanten, waar je zo’n 1 tot 2 uur bent. Bij de klanten thuis ondersteun je bij de dagelijkse dingen. Dit doe je niet door alles van de klant over te nemen, maar je ondersteunt op zo’n manier dat je hun zelfredzaamheid positief stimuleert.
Bovendien komt door de verstijving van de grote teen tijdens het lopen het been niet goed van de grond, zodat de Psoas-spier te hard moet trekken om het been van de grond te krijgen. Deze hecht aan op de ruggengraat bij L1-4. Dit veroorzaakt verdraaiingen in de rug, met als gevolg het scheuren van de tussenwervelschijf op L4-L5niveau. Dit geeft hernia-achtige onderrugklachten.
Meer informatie
Voor meer informatie en het maken van een online afspraak: voetflex. nl. Telefoon: 055-4560105 (maandag tot en met vrijdag van 8.00 tot 18.00 uur). Openingstijden: dinsdagmiddag op het adres Basic Fit, Dreef 10, 7202 AG Zutphen.
PS Wil je graag op een locatie van Sensire werken? Ook dan hebben we plek voor je.
Ben je al helpende en heb je nog geen “plus”-aantekening? We gaan je daarbij helpen. Je bent van harte welkom.
♥ Veel tijd voor je klant
Wij helpen je bij het behalen van je “plus”-aantekening
Ook op latere leeftijd!
Start wanneer je wilt






Niet twijfelen maar doen! Scan mij






- ADVERTORIAL2

Nieuws


uit de gemeente Zutphen
Gregoriaans Getijdenkoor zingt in Sint Jan

Van zondag 24 tot zaterdag 30 maart vieren de katholieke gelovigen de ‘Goede Week’. Als een van de weinige Gregoriaans Getijdenkoren in Nederland verzorgt het Gregoriaans Getijdenkoor Sint Jan naast de Vespers van Palmzondag, ook op Stille Zaterdag de Metten en Lauden.
“In de Rooms-Katholieke Kerk wordt op Stille Zaterdag net als op Goede Vrijdag de Eucharistie in het geheel niet gevierd. In tegenstelling tot Goede Vrijdag wordt
op Paaszaterdag zelfs de Heilige Communie niet uitgereikt. Ook de klokken luiden niet op die dag. De gehele dag ziet de kerk er kaal uit: geen bloemen, geen kaarsen, geen doek (= altaardwaal) op het altaar. Op die dag wordt in de kerk getreurd om de dood van Jezus, net zoals zijn leerlingen toen deden. Stille Zaterdag is bij uitstek een dag om te geloven en te hopen. In menselijk opzicht is alles uitzichtloos en vergeefs geworden. Er is alleen onmacht. Met onze menselijke vermogens komen we
Werken met een ZZP-er: een vloek of een zegen?

mr. P. (Priscilla) Trip advocaat arbeidsrecht en insolventierecht
In de huidige arbeidsmarkt blijft het aantal ZZP-ers nog steeds toenemen. Meer vrijheid qua tijdsindeling voor de ZZP-er, maar soms ook een goedkoper alternatief voor een opdrachtgever of simpelweg de enige mogelijkheid om mensen aan te trekken. Ook wij krijgen in onze praktijk regelmatig de vraag of wij een overeenkomst van opdracht voor een ZZP-er op willen stellen. Dat doen wij natuurlijk graag, maar we schetsen daarbij wel de risico’s. Want hoewel ZZP-ers en opdrachtgevers vaak zelf de keuze maken voor het zelfstandig ondernemerschap, vindt onze overheid daar wel wat van. Er is nieuwe wetgeving in de maak met (o.a.) als doel het aantal ZZP-ers terug te dringen en we zien we ook in de rechtspraak dat zelfstandigen bij discussie regelmatig toch werknemer blijken te zijn.
Een goed voorbeeld daarvan is de uitspraak van de rechtbank van begin februari dit jaar waarin is geoordeeld dat een corrector die jarenlang als ZZP-er bij de Volkskrant werkte eigenlijk in loondienst had moeten worden genomen. Deze correcter werkte vanaf 2011 voor de Volkskrant, waarna de Volkskrant hem vorig jaar heeft laten weten zijn overeenkomst van opdracht per september 2023 te willen beëindigen. Er was vanwege organisatorische redenen geen corrector meer nodig. De corrector spande een procedure aan met de stelling dat er eigenlijk sprake was van een arbeidsovereenkomst en dat om die reden opzegging niet zomaar mogelijk was. Hij stelde daartoe dat hij op kantoor werkte, volgens een bepaald rooster, dat hij instructies kreeg en ook een laptop van de Volkskrant gebruikte. De rechter stelde hem in het gelijk en oordeelde dat er inderdaad sprake was van een arbeidsovereenkomst, op basis waarvan hij recht had op achterstallig loon vanaf september 2023 en op vakantiegeld, werktijdentoeslag en een winstdeling over de afgelopen vijf jaar. Ook de beëindiging van die arbeidsovereenkomst was niet zomaar mogelijk door opzegging.
Bovenstaande uitspraak laat zien dat het niet alleen belangrijk is om de afspraken goed vast te leggen, maar om daar in de praktijk ook op een goede manier uitvoering aan te geven. Wil je daarover een keer sparren, neem dan gerust contact op met één van onze arbeidsrechtspecialisten.
Europaweg 202A - Apeldoorn - Tel. (055) 526 20 20 apeldoorn@dommerholt.nl - www.dommerholt.nl
nergens meer. In de vroege morgenuren van paaszaterdag in de verstilde ruimte van de Sint Janskerk in Zutphen zingt het koor de Metten en Lauden, twee gedeelten uit het Kerkelijk Getijdengebed, als voorbereiding op het Hoogfeest van Pasen”, vertelt Tom Schenk.
“De Metten en Lauden zijn het begin van het dagelijks koorgebed, maar krijgen op deze dag na de kruisiging en graflegging van Jezus een diepere betekenis door de indrukwekkende meditaties in een
opeenvolging van Psalmen, Klaagzangen van Jeremia en prachtige Responsoria. Door de eeuwen heen zijn de mooiste gezangen uit het Gregoriaans in deze vroege liturgie bijeengebracht. Als ware het in droefheid en berusting de dodenwacht bij Zijn graf, maar daarnaast ook vol verwachting over dat wat komen gaat. Het ritueel met 15 kaarsen, 14 ongebleekte als rouw en één witte als symbool van Christus en Zijn Opstanding op de driehoekige kaarsenegge, geeft een extra dimensie aan deze viering.” Onbekend maakt onbemind “Deze liturgie is daarbuiten in veel parochiekerken onbekend en onbekend maakt al gauw onbemind. Toch heeft deze vorm van liturgie een eigen aantrekkingskracht en bestaat er een groeiende belangstelling voor deze meditatieve en spirituele vieringen. Het afgelopen jaar is het aantal bezoekers van onze viering sterk toegenomen en zien wij dat de bezoekers uit de verre regio komen.”
Met reuma in warm water

Bewegen is belangrijk voor mensen met reumatische aandoeningen. Oefenen in het verwarmde water is daarvoor zeer geschikt. Oefeningen die de spieren activeren, inspanning en ontspanning.
De reumavereniging Zutphen en omstreken biedt deze therapie al vele jaren. Deze hydrotherapie wordt bijna dagelijks aangeboden in de zwembaden van behandelcentrum Sensire en De IJsselslag in Zutphen. De belangstelling is groot. Voor meer informatie en opgave: Jitske Lautenbach, telefoon 0313-652593.
Bekendmakingen

Gemeente Zutphen
Vergunningen verleend Zutphen en omgeving
- Warnsveldseweg, ter hoogte van nr 105 in Zutphen, kappen van een boom
- Loohorst 12b in Zutphen, plaatsen van handelsreclame
- Turfstraat 10, Zutphen, exploitatievergunning horeca verleend
- Ien Dalessingel, aanwijzen parkeerplaats voor opladen elektrisch voertuig
- Loohorst 12b, Zutphen, plaatsen van handelsreclame
- Bronsbergen 8, Zutphen, omgevingsvergunning voor vervangen van kozijnen en aanpassing constructie
- Helbergse Waard ong (kavel 21) in Zutphen, bouwen van een nieuwe woning
Vergunningen aangevraagd Zutphen en omgeving
- Noorderhavenkade 23 in Zutphen, wijzigen van voorgevel
- Houtmarkt 46, Zutphen, plaatsen terrasschotten/ windschermen
- Bakkerstraat 19, Zutphen, plaatsen van isolerend monumentenglas
- Houtmarkt, Zutphen, Zomeravondconcert op 5 juli
- Van Dorenborchstraat 1, Zutphen, gereserveerde gehandicaptenparkeerplaats
- Weg naar Voorst (De Hoven), Oude IJsselbrug, IJsselkade, Marspoortstraat, Groenmarkt, Houtmarkt, Zaadmarkt, Drogenapsteeg, Martinetsingel, Boompjeswal, Laarstraat, Warnsveldseweg, Rijksstraatweg, doorkomst Roparun in Zutphen
Zutphen gaat weer aan de wandel
Met gepaste trots kan Burgerbelang aankondigen dat de Avondvierdaagse, het wandelevenement dat in het hart van vele Zutphenaren en Warnsvelders ligt, na vijf jaar afwezigheid weer zal plaatsvinden. De gemeenteraad van Zutphen ging tijdens de raadsvergadering van 26 februari unaniem akkoord met het voorstel van Burgerbelang om de herstart financieel te ondersteunen.
In de afgelopen jaren is er achter de schermen hard gewerkt om de Avondvierdaagse weer mogelijk te maken. Maatschappelijke organisaties zoals Actief Zutphen, Perspectief, GGNet, Vitaal Hanzepark en de scouting hebben hun krachten gebundeld. Samen met de inzet

van Stichting A4D, die een gedetailleerde begroting van € 9.287,23 voor de opstartkosten heeft opgesteld, staat niets de terugkeer van dit evenement nog in de weg.
Wethouder Rick Verschure had recentelijk de verwachting uitgesproken dat het voor 80% zeker was dat de
Aanmelden voor onze nieuwsbrief?

Avondvierdaagse dit jaar zal doorgaan. Dit nieuws werd met open armen ontvangen, aangezien sport en beweging topprioriteiten zijn voor de gemeente Zutphen. Het evenement, waar in het verleden alle basisscholen van Zutphen en Warnsveld aan deelnamen, staat symbool
voor gemeenschapszin en het plezier van samen sporten en bewegen. Om de terugkeer van de Avondvierdaagse het laatste duwtje te geven, heeft Burgerbelang het college opgeroepen om eenmalig de opstartkosten te dekken. Daarnaast wordt voorgesteld om in gesprek te gaan met Stichting A4D om te zorgen dat de Avondvierdaagse vanaf 2025 een jaarlijks terugkerend succes wordt. Burgerbelang kijkt uit naar de hernieuwde samenwerking tussen de gemeente, maatschappelijke organisaties, scholen, en alle inwoners van Zutphen en Warnsveld om van de Avondvierdaagse 2024 een onvergetelijk evenement te maken. “Samen zetten we gemeente Zutphen in beweging!”
Wij zijn op zoek naar:
PARTTIME/FULLTIME MEDEWERKER BEDIENING
Wat wij zoeken in jou:
Vakantiemedewerkers en student voor het seizoen Solliciteer direct via e-mail (info@veluwshof.nl) of bel 055-3781777 onder vermelding
Je bent vriendelijk en gastvrij
Je loopt net een stapje verder
Je bent een echte team player



3
Krimweg 152 - 7351 TM - Hoenderloo - www.ruggestee.nl
van Dhr. M.R. Van Meerten
Scan de QR- CODE!
MAG JE WERKNEMER JOU VOOR
PAAR PROCENT ZIEK HOUDEN?

Een werkgever moet gedurende ziekte het loon gedurende maximaal 104 weken doorbetalen. Als de werknemer net voor de afloop van 104 weken herstelt, het werk hervat, en na vier weken wederom ziek uitvalt, begint een nieuwe periode van 104 weken waarin de werkgever het loon moet doorbetalen. Vandaar dat sommige werkgevers de werknemer op dat moment voor een klein percentage ziek houden. Dit voorkomt dat er een nieuwe periode van 104 weken start. Maar mag dit ook?
Het korte antwoord is ‘nee’. Al in 2009 oordeelde de Rechtbank Noord-Nederland dat het administratief ziek houden van een werknemer die de bedongen arbeid volledig verricht, in strijd is met art. 7:629, lid 10 BW. Het gaat hier om situaties dat de werknemer na langdurige arbeidsongeschiktheid volledig werkt en de eigen functie uitvoert. In die situatie mag de werkgever de werknemer niet gedurende enige tijd voor een beperkt percentage ziek houden. Als de werknemer niet volledig werkt, maar bijvoorbeeld bepaalde taken die bij de functie horen niet kan uitvoeren dan ligt de situatie anders en kan de werkgever wellicht de werknemer voor een percentage ziek houden.
Mr. Sigrid Schinkel schinkel@advocatenkantoorschinkel.nl www.advocatenkantoorschinkel.nl
tel: 0570-547120
Van Twickelostraat 13, 7411 SC Deventer



‘Chauffeur op regiotaxi enorm dankbaar werk’

Jacqueline van Schaijk is vijf jaar geleden bij Van Driel in Oss begonnen als chauffeur op de regiotaxi. Sinds een aantal maanden is ze teamleider, waarbij ze de spil vormt tussen de chauffeurs op de weg en het kantoor. Zij vertelt over hoe mooi en belangrijk het dagelijks vervoer van mensen en groepen is.
Onregelma�ge bezorging?
Laat het ons weten
Via
Klachten@stedendriehoek.nl
055-3034901



















“Ik heb nu een andere functie binnen de organisatie, maar ik spreek uit ervaring als ik zeg dat chauffeur zijn heel dankbaar werk is. Je kunt de mensen op een veilige en leuke manier van A naar B vervoeren. Onderweg knoop je een praatje aan met je passagiers. Als mensen met een chagrijnig gezicht de bus instappen en er met een glimlach weer uitkomen, heb je gewoon een toprit gehad! Iedere rit is ook weer uniek. Ik heb heel veel verschillende mensen tussen de 3 en 98 jaar in mijn wagen vervoerd: kinderen,
ouderen, mensen voor de dagbesteding, enzovoorts. Voor iedere passagier die je ophaalt, stap je even uit, je opent de deur, helpt met in- en uitstappen wanneer nodig. Kleintjes zet je in de kinderzitjes, anderen help je met het omdoen van de gordel, maar je doet alles altijd eerst in overleg met je passagiers.”
Geen abnormale eisen “Wie bij ons komt werken moet houden van dat sociale aspect. Je vindt het leuk om een gezellig gesprekje te voeren met de passagiers. Daarbij is
het belangrijk dat je er verzorgd en netjes uitziet en de Nederlandse taal goed beheerst. Het is belangrijk dat, waar je ook komt, je namen kunt lezen en goed kunt uitspreken. Je wilt natuurlijk altijd de juiste persoon meenemen. Alle medewerkers worden binnen de Van Driel Academy getraind op een servicegerichte en dienstbare instelling. Dus, zit je graag achter het stuur, maar vind je het sociale aspect net zo belangrijk? Solliciteer dan naar de functie van chauffeur regiotaxi bij ons!”
Op zaterdag 16 maart houdt Van Driel een inloopdag. Aanmelden kan via www.werkenbijvandriel.nl/ bedrijfsinformatie/inloopdag. Zie ook de website: www. vandrielgroep.nl







- ADVERTORIAL -
.nl Iedereen in beweging als missie Serviceloket station blijft open KOZIJNEN-‘Gordiaanse knoop nu oplossen’--kanker uilen Zutphen .nl Tandarts Degen 4
Stadskade 406 | Apeldoorn 055 303 0970 WWW.EIJGELAAR.NL/APELDOORN Grafmonumenten EIJGELAAR GEDENKEN Elke zaterdaggeopend BANKTOPPER Kijk voor alle 35 vestigingen op www.montel.nl Zeker zijn van korting? Maak een afspraak! Montèl Traffic Hoekbank. Banktopperprijs € 2399.Nu met 10% extra korting 2159.Montèl Blazer 3-zits. In stof vanaf 999.Nu met 10% extra korting 899.VIP DAYS 10% KORTING Alléén dit weekend Start donderdag 7 maart t/m zondag 10 maart Montèl Target Mito Hoekbank. In stof van € 2699.voor € 2199.Nu met 10% extra korting 1979.-* *excl. sierkussens. BANKTOPPER KINDERBEURS XXL 17 maart HANZEHAL ZUTPHEN 150 kramen nieuw & 2e hands voor kids van 0 t/m 12 jaar. Kinderkleding, speelgoed, kinderboeken en kinderaccessoires. Info en online entreetickets à � 3,via www.kinderbeursxxl.nl
Vereniging De Hoven blijkt een schot in de roos

ZUTPHEN - In De Hoven is een kleine groep mensen (jong en oud) actief in de schietsport. Met een luchtgeweer of luchtpistool wordt op een kaart geschoten die op tien meter afstand staat. “Dat lijkt dichtbij, maar je zult merken dat het best lastig is de roos te raken. Concentratie, de juiste houding en uithoudingsvermogen zijn belangrijk voor een reeks goede schoten”, zegt Erica Risiglione. Zij beantwoordt ook met veel plezier enkele vragen.
Is de schietsport voor iedereen?
“Jazeker! Vanaf 8 jaar mag je al lid worden en je kunt doorgaan zolang als jij het wil. Voor de jongeren zijn er speciale ondersteunende hulpmiddelen die het schieten lichter maken en daarmee het lichaam niet te veel belasten. En het mooie is, dat geldt ook voor de oudere schutter. Uiteraard heeft die laatste schutter de keuze.
Sommigen gebruiken de hulpmiddelen, anderen niet. Veiligheid staat voorop, daar wordt veel aandacht aan besteed. Maar nog
belangrijker is de lol hebben in het schieten in de roos.”
Kan ik het ook gewoon eens proberen?
“De komende maanden zijn er meerdere manieren om kennis te maken met onze schietvereniging en met de sport. Er zijn inloopavonden en introductiecursussen. De introductiecursus duurt drie avonden. Op de woensdagen 13, 20 en 27 maart van 19.30 tot ongeveer 21.00 uur is iedereen welkom. Met maximaal zes deelnemers leer je elke avond iets meer over het schieten met een


luchtgeweer, oefen je en kun je zelfs deelnemen aan de bekwaamheidsproef aan het einde van de derde avond. De kosten bedragen €30,- voor de drie avonden. Dit is inclusief alle materiaal, gebruik van een geweer en natuurlijk een kopje koffie of thee bij binnenkomst.”
“De introductiecursus voor 55-plussers duurt vier avonden. Op de woensdagen 17 en 24 april, 1 en 8 mei van 19.30 tot 21.00 uur. Ook hier wordt elke week weer wat dieper gekeken naar je techniek en wordt op 8 mei afgesloten met een heuse onderlinge
wedstrijd. De kosten voor deze vier avonden zijn €40,-. Als je op de kalender van www.svdehoven.nl kijkt, zie je op welke dinsdagavond je gewoon binnen kunt lopen. Onze trainer vertelt je dan meer over de sport en uiteraard kun je een paar schoten proberen. Vind je het leuk, dan is het verstandig om toch de introductiecursus te volgen en meer te leren en te oefenen.”
Is het ook nog gezellig?
“Ondanks dat het schieten zelf een serieuze sport is, is er altijd tijd voor gezelligheid. Vooraf een kop koffie in de kantine, en achteraf een biertje of gewoon een glas frisdrank. Samen naar wedstrijden als je er klaar voor bent of naast de dinsdag nog extra trainen met je medeschutters op donderdag, om toch vaker die mooie 10 te schieten. We hebben allemaal hetzelfde ‘doel’ en iedereen is bereid elkaar te helpen goede resultaten te behalen.”
Hoe kan ik mij aanmelden? “Wil je graag aan één van de introductiecursussen deelnemen? Stuur dan een mail naar info@svdehoven.nl. Geef daarbij wel even aan voor welke cursus je je aan wil melden. Wil je een keer langskomen bij een inloopavond, geef dan door welke avond je voorkeur heeft.”
Vier saxofoons in klassiek concert

BRUMMEN - Op zondag 17 maart vanaf 15.30 uur speelt het Berlage Saxophone Quartet in de Kamermuziekserie, georganiseerd door de Werkgroep Kamermuziek, in de Pancratiuskerk aan Kerkstraat 17 in Brummen. “Het is misschien verrassend om vier saxofoons in een klassiek concert te horen, maar dit kwartet laat u ervan genieten en laat u horen hoe goed ze passen bij deze muziek”, aldus de organisatie.
Geroemd om zijn ‘muzikale speelplezier, natuurlijke flair, loepzuiver en ambachtelijk spel, waarin ze zoeken naar het uiterste’ (Jury Dutch Classical Talent), toont het Berlage Saxophone Quartet graag zijn veelzijdigheid aan een breed publiek met eigen arrangementen en werken uit verschillende eeuwen en stijlen. Het Berlage Saxophone Quartet is opgericht in 2008 en bestaat uit Eva van Grinsven, Lars Niederstrasser, Juani Palop en Peter Vigh. Dit saxofoonkwartet wordt gezien als een voorloper van een nieuwe generatie saxofonisten. Ze spelen muziek van Debussy, Glazoenov, Darvishi en Dvorák.
Sommige strijkkwartetten lenen zich zeer goed voor transcriptie voor saxofoon. Zo ook het beroemde en geliefde Amerikaanse kwartet van Antonin Dvorák, dat hiermee een heel eigen en verrassende signatuur krijgt. Glazoenov schreef zijn kwartet speciaal voor saxofoon, die in die tijd als nieuw instrument net zijn intrede had gedaan. Toegangskaarten à € 20,zijn te koop via de website www.brummencultuur.nl. Kinderen tot en met 16 jaar hebben na opgave gratis toegang. “Na afloop serveren wij een (gratis) drankje zodat u nog even uw impressies van het concert met elkaar kunt delen.”
WHC DE SCHERPENBERGH
Op zoek naar een bijbaantje? Meld je snel aan voor een krantenwijk bij jou in de buurt!
Maak kans op een Playstation 5

Bezorg bij jou in de buurt
Lekker buiten aan het werk
Bepaal je eigen werktijden
Ook leuk als vakantiebaantje




Meer weten over een krantenwijk bij All-Inn? Scan de qr-code of ga naar allinnbezorger.nl/playstation

Golf-en Business Club De Scherpenbergh
Albaweg 43, 7364 CB Lieren T. 055-5051262

Vrije golfer?
Laat je registreren bij WHC De Scherpenbergh en profiteer van de voordelen!
Een jaarlijkse contribu�e van € 130 en eenmalig inschrijfgeld van € 40 met deze faciliteiten:
• NGF en handicap registra�e, inclusief verzekering en gol�ournaal.
• Kor�ngen tot 30% op de greenfee prijzen van Golf- en Businessclub De Scherpenbergh.
• Kosteloos gebruik van de oefenfaciliteiten van Golf- en Businessclub De Scherpenbergh.
• Deelname aan leuke wedstrijden die maandelijks worden georganiseerd.
• De mogelijkheid om deel te nemen aan het lesaanbod van Golfschool Apeldoorn. Beginnen met golfen was nog nooit zo eenvoudig!
Complete beginners golfcursus voor € 195!
• 12 uren golfles van een gediplomeerde golfprofessional.
• Twee golfregelavonden inclusief NGF regelexamen.
• Baanpermissie garantie bij aansluitend lidmaatschap van WHC De Scherpenbergh
• Geen inschrijfgeld WHC De Scherpenbergh.
• Onafhankelijk advies bij de aanschaf van een golfuitrusting. Voor vragen en aanmeldingen?

Golf@scherpenbergh.nl, 055 5051262, www.whcdescherpenbergh.nl

5


GAAT MET PENSIOEN
Koop nu uw naaimachine of lockmachine!!!
Voor reparatie en onderhoud van uw machine kunt u dit jaar nog bij ons terecht.
En ook voor wol, stoffen, borduren en fournituren
DE OPRUIMING IS BEGONNEN!!!!!


Haken & Ogen
naaimachinespeciaalzaak
Ruys de Beerenbrouckstraat 13, 7204 MN Zutphen
Openingstijden:
Dinsdag t/m Zaterdag 10.00 tot 16.00 uur
Telefoon: 0575-519222


Bezoek de vernieuwde circulair gebouwde rioolwaterzuivering Terwolde
Gotink Catering zet maaltijdservice Rosengaerde voort
STEDENDRIEHOEKDonderdag 11 januari 2024 was een belangrijke dag voor zorgcentrum Rosengaerde Dalfsen en zijn cliënten. Op deze koude donderdag hebben meerdere maaltijdleveranciers zichzelf gepresenteerd om de inmiddels vijftig jaar bestaande maaltijdservice van Rosengaerde voort te zetten. Vanwege de verhuizing naar de nieuwbouw zal einde van dit jaar de grootkeuken sluiten.
De animo voor het voortzetten van de warme maaltijdservice was groot. Een selectiecommissie bestaande uit medewerkers, clienten en vrijwilligers van Rosengaerde gaf advies aan de cliëntenraad. Zij waren het er unaniem over eens dat Gotink Catering de meest geschikte partij was. Door de jarenlange ervaring in het leveren van warme maaltijden aan huis is de keuze uiteindelijk op deze leverancier gevallen.
Gotink Catering uit Deventer is in 42 jaar uitgegroeid tot een bedrijf dat niet alleen maaltijden brengt in Deventer, maar ook in Raalte en Heino. Begin 2023 heeft Gotink Catering de maaltijdservice van OCO in Ommen met succes doorgezet. “Na Ommen is dit voor ons een logische volgende stap”, zegt directeur Bert

Ontdek de ‘reis van het rioolwater’. Loop mee met





Gotink. “In deze regio woont een dankbare doelgroep die maakt dat het ontzettend eervol werk is wat we doen.” Al is de verhuizing van het verpleeghuis pas begin volgend jaar, het heeft nu al impact op de organisatie, de cliënten en de omgeving. Rosengaerde wil hierom de selectie van een maaltijdleverancier afronden om zo snel mogelijk duidelijkheid te geven.
Inmiddels is de intentieverklaring getekend, de bijeenkomst voor alle vrijwillige maaltijdbezorgers is gepland en zaterdag 22 juni is er een inloopmiddag bij Rosengaerde voor maaltijdcliënten en geïnteresseerden. “Tijdens de inloopmiddag is er een proeverij waarbij medewerkers van Gotink Catering aanwezig zijn om vragen te beantwoorden”, vertelt Henny Goos van Rosengaerde. “Alle

maaltijdcliënten ontvangen hiervoor een uitnodiging en meer informatie.”
Zowel Rosengaerde als Gotink Catering zijn achter de schermen hard aan het werk om de overgang zo soepel mogelijk te laten verlopen. De maaltijdcliënten mogen zo min mogelijk last hebben van deze verandering.



































6
OPEN DAG 16 MAART BANDIJK 3 TERWOLDE 10.00 - 14.00
de rondleiding en zie wat er met jouw rioolwater gebeurt. We vertellen je ook graag meer over hoe we de zuivering gebouwd hebben. Hier komt veel (water)bouw en techniek bij kijken. WERKTUIGBOUWKUNDE ELEKTROTECHNIEK CIVIELE TECHNIEK PROCESTECHNOLOGIE WATERMANAGEMENT Groene vingers, hart voor dieren of juist oog voor techniek? Bij Zone.college vind je altijd een mbo-opleiding die aansluit bij jouw talenten en interesses. Ontdek het zelf tijdens onze voorlichtingsavond!
Deventer meld je aan! www.zone.college Voorlichtingsavond Maak kennis met ons mbo
21 maart


Voor wie de memo gemist heeft: het is de Week van de Lentekriebels. Dat is een nationale projectweek voor speciaal- en basisonderwijs, georganiseerd door Rutgers en de GGD. Scholen die meedoen geven een week lang les over relaties,
LENTEGRIEZELS
seksualiteit en weerbaarheid.
Dit jaar is het thema ‘weerbaar online’, waarbij de koters leren hoe ze veilig gebruik kunnen maken van internet en sociale media. Ik heb even contact opgenomen met Rutgers en de GGD of ze dat lesmateriaal niet ook beschikbaar kunnen stellen voor volwassenen. Ik ken nog wel een aantal adresjes in medialand die een aantal cursussen kunnen gebruiken. ‘Wanneer verstuur je een dickpic?’ of ‘Hoe gedraag ik me minder als een lul?’, ik noem maar een zijstraat.
Daarbij komt er een uitgebreide workshop ‘hoe flikker ik iemand niet voor de bus?’. Die is speciaal














voor (oud-)medewerkers van horrorhoofdredacties en leidinggevenden. Dat is tegenwoordig zo wonderlijk, hè? Op de werkvloer mag je als eindbaas nog geen kik geven of je wordt als intimiderend gezien, maar medewerkers mogen wel van alles en nog wat dat internet opmieteren. Over hoe een eikel of eikelin je bent geweest en wat er allemaal fout ging. Dat is toch gek? Je vecht iets uit in de arena, of je houdt je mond. Dat getwitterbis achter iemands rug om. Lekker dapper! Dan origamiën we ook een cursus ‘hoe ben je ambitieus zonder te schreeuwen’ en ‘hoe word ik geen Mart Smeets?’. Mag ik dat zeggen? Ja, dat mag ik zeggen.
Volgens mij is die Week van de Lentekriebels zo gek nog niet. Het is belangrijk dat kinderen leren wat seks is, hoe ze met elkaars en eigen lichaam omgaan en hoe belangrijk het is om grenzen aan te geven. De volwassenen die aanstoot geven aan een week waarin dat soort precaire zaken besproken worden, die moeten juíst eens zo een klasje meedoen. Het zegt iets, als je intieme zaken liever niet bespreekbaar wil maken. Dan was juist zo een voorlichting niet gek geweest. Wat is er mooier dan liefde, seks en alles wat daarbij komt kijken? Tijd om de bloemetjes en bijtjes gewoon te benoemen. Als je weet waar je op moet letten, zie je mooiere dingen.
32 noodhulpbureaus in honderd gemeenten (vervolg voorpagina)
In 1914 richtte Koningin Wilhelmina de rechtsvoorganger van SUN Nederland op: het Koninklijk Nationaal Comité. Deze organisatie had als doel om individuele noodsituaties snel op te pakken en lokale steuncomités te bundelen en ondersteunen. Met de jaren is de SUN-werkwijze met de tijd mee veranderd, maar nog steeds initieert, faciliteert, innoveert en agendeert SUN Nederland in 2024 initiatieven rondom noodhulp. SUN Nederland streeft daarbij naar landelijke dekking van noodhulp, omdat zij vindt dat het niet van toeval mag afhangen of iemand met urgente noden financiële ondersteuning kan krijgen.
Op dit moment zijn er 32 noodhulpbureaus in ruim honderd gemeenten in Nederland actief. SUN Zutphen is recent opgericht. Hulp- en dienstverleners kunnen aanvragen indienen voor hun cliënten met financiële noden als deze nergens anders meer terecht kunnen. SUN-noodhulpbureaus dragen bijvoorbeeld bij aan woninginrichting, medische kosten, educatie, kleding, voedsel of het betalen van eerste maand huur of borg. Met een gift en/of renteloze lening bieden zij een vangnet en perspectief. Zie de landkaart op www.sunnederland.nl voor een overzicht van noodhulpbureaus en voor animaties met
een uitleg over SUN-noodhulp. Op dit moment leven ruim 1 miljoen mensen rond de armoedegrens en groeit 1 op de 13 kinderen in Nederland op in armoede. Daarnaast zijn er ruim 725.000 huishoudens met problematische schulden en hebben ook steeds meer mensen met inkomen uit werk het moeilijk om rond te komen. Koning Willem-Alexander spreekt tijdens het werkbezoek over het 110-jarig bestaan van SUN-noodhulp(bureaus) en de kerntaken van SUN Nederland. Daarnaast gaat de koning in gesprek over het onderzoek van de Vrije Universiteit. Hierin is onderzocht welk effect een gift en/of renteloze lening heeft op zowel begunstigden als op hulp- en dienstverleners en gemeenten. Daarna vertellen enkele mensen die een gift hebben ontvangen zelf wat dit voor hen heeft betekend.
Afsluitend wordt aan de koning een herdenkingsmunt uitgereikt die in 1939 door het Koningshuis is uitgegeven ter gelegenheid van de geboorte van Prinses Irene. De Nederlandse bevolking kon destijds dit soort herdenkingsmunten kopen. De opbrengst kwam ten goede aan de rechtsvoorganger van SUN Nederland om noodhulp mogelijk te maken. Tegenwoordig zijn SUN Nederland en de noodhulpbureaus afhankelijk van donaties en werken zij intensief samen met gemeenten.









MODEMALL WILP• 5.000 M2 MODE & LIFESTYLE• RIJKSSTRAATWEG 38• 0571 261 755 WWW.PIETZOOMERS.COM *M.U.V. NIEUWE EN STANDAARD COLLECTIES. TOTALE NAJAARS EN WINTERCOLLECTIE 70% KORTING* DAMES DE UITSLUITENDWINKEL IN
HEREN 50% 7
FINALE SALE
Columnist
VOORJAARACTIE


Wat je krijgt
• Je ontvangt DISQ-apparatuur t.w.v. € 199,-
• Start met onze unieke 21-days challenge
• Online support van onze personal trainers.
• Toegang tot de DISQ Online Gym (met extra workouts en challenges).
• Na 6 maanden mag je de DISQ-apparatuur houden (Stop je binnen die periode dan stuur je hem gewoon terug)
• Bonus: het DISQ voedings- en recepten e-book.
• Maandelijks opzegbaar




Uitgebreide collectie verlichting voor elk budget
RIJSSEN - De klanten komen van heinde en verre om bij EVI Verlichting de lamp te vinden waarnaar ze op zoek zijn. In het opvallende pand aan de Wierdensestraat 52 in Rijssen treft de bezoeker op maar liefst 500 m2 en over drie verdiepingen namelijk een zeer uitgebreide collectie lampen aan. Bent u op zoek naar moderne verlichting of juist een klassieke lamp? Gaat de voorkeur uit naar ledverlichting of past een sfeervolle plafondlamp het beste in uw interieur? Bij EVI Verlichting is het allemaal te vinden. Ruim en betaalbaar assortiment Bij EVI Verlichting kan de klant dus terecht voor mooie lampen in alle prijsklassen, voor elk budget. Er zijn lampen van het designmerk By Eve, maar ook lampen van het populaire merk Highlight. Daarnaast is EVI onder meer dealer van merken als Villaflor, Freelight, Steinhauer en Masterlight.
Lichtadvies op maat Wanneer u de juiste sfeer wilt creëren in huis of kantoor omdat u, samen met collega’s, plezierig wilt kunnen werken, dan heeft u misschien behoefte aan professioneel lichtadvies. Ook daarvoor bent u bij EVI Verlichting aan het juiste

adres. Maak vrijblijvend een afspraak met een specialist voor een passend advies op maat.
Lampen online Behalve de fysieke winkel heeft EVI Verlichting ook een eigen webshop: Lampenhuis.nl. Hier vindt u een enorm assortiment aan lampen. Ongeacht smaak, budget of stijl, via Lampenhuis.nl is de kans groot dat u slaagt in de zoektocht naar een mooie hang-, wand-, vloer- of leeslamp.
Tiffany lampen Alle lampen van het
Profiteer nu tot € 5.200 voordeel op een nieuwe Hyundai.
Direct leverbaar bij Herwers.












populaire merk Tiffany zijn uniek door het specifieke kleurgebruik en de selectie van het glas. Wanneer u op zoek bent naar zo’n originele Tiffany lamp, neem dan eens een kijkje op de webshop tiffanylampenhuis.nl. Deze biedt een uitgebreide collectie lampen, windlichten en glaspanelen.
EVI Verlichting is gevestigd aan Wierdensestraat 52 in Rijssen.
Voor meer informatie, telefoon 0548-512295, e-mail info@eviverlichting.nl en website www.eviverlichting.nl












































en grote momenten. Of wat te denken van de BAYON. Een gestroomlijnde CUV die compact oogt, maar verrassend ruim vanbinnen is. Of liever een stoere TUCSON die meermalen beloond, bekroond en geroemd is o.a. als ‘Beste geteste Plug-in Hybrid SUV en ‘Beste Familieauto’. En er zijn meer modellen met aantrekkelijke kortingen tot wel € 5.200 en uit voorraad leverbaar. Dus profiteer nu en maak een proefrit in de Hyundai van je keuze.
Kom nu langs voor een proefrit en offerte op maat.





Ontdek onze voorraad.

- ADVERTORIAL -
VOORJAAR ACTIE 27,95 Gecombineerd verbruik: 1,38 - 6,6 (l/100 km) / 15,2 - 72,5 (km/l); CO2 - emissie: 31 - 152 (gr/km). Uitstoot- en brandstofverbruiksgegevens zijn gebaseerd op tests die zijn uitgevoerd volgens de Europese richtlijnen EU 2018/1832 en 2017/1151. De vermelde WLTP-waarden voor het gecombineerde brandstofverbruik en de CO2-uitstoot zijn overeenkomstig de nieuwe WLTP-testmethodiek. De waarden zijn afhankelijk van de gekozen uitvoering en wielmaat. De Hyundai ‘5 jaar garantie zonder kilometerbeperking’ en de ‘8 jaar of 160.000 kilometer batterijgarantie’ zijn alleen van toepassing op Hyundai-voertuigen die initieel aan een eindgebruiker zijn verkocht door een erkend Hyundai-dealer. De Herwers Smart Deals-actie bestaat uit een maximaal voordeel tot € 5.200 op het aankoopbedrag van een geselecteerd voorraadmodel en zolang de voorraad strekt. Actie geldt bij een getekende koopovereenkomst t/m 31-03-2024 met een uiterste registratiedatum van één maand na koopovereenkomst. Actie is van toepassing op particuliere transacties. Acties zijn niet geldig in combinatie met andere lopende acties. Genoemde prijs is een adviesprijs en is excl. metallic lak en eventuele opties. Genoemde bedragen zijn onder voorbehoud van prijswijzigingen en verschillen per model. Kijk voor prijzen en voorwaarden op hyundai.nl of vraag ernaar bij de erkende Hyundai-dealer. De gedetailleerde garantievoorwaarden zijn beschreven in het service& garantieboekje. Afgebeeld model en kleur kunnen afwijken van standaarduitvoering en beschikbare productiekleur. Druk- en zetfouten voorbehouden. Ontdek meer op hyundai.com/nl/herwers Apeldoorn: Laan van de Dierenriem 29, tel. 055 - 369 6212 Arnhem: Hazenkamp 15, tel. 026 - 362 80 80 Deventer: Solingenstraat 3, tel. 0570 - 519 360 Doetinchem: Plakhorstweg 14, tel. 0314 - 333 055 Tiel: Stephensonstraat 21, tel. 0344 - 630 500 Veenendaal: Galileistraat 12, tel. 0318 - 529 555 Een gloednieuwe Hyundai, scherp geprijsd en direct leverbaar? Het kan bij Herwers Hyundai. Zo rijd je bijvoorbeeld direct weg in de Hyundai i10. Deze wendbare auto is perfect voor kleine ruimtes
8
9
Omgaan met verlies en rouw
BRUMMEN - Op woensdag
13 maart start Stichting Welzijn Brummen met een contactgroep ‘Omgaan met verlies’. De contactgroep bestaat uit acht deelnemers die onlangs, of langere tijd geleden, iemand hebben verloren en die een weg zoeken om hiermee om te gaan. De groep wordt begeleid door Karin van Aalst, deskundig professional op het gebied van verdriet, verlies en rouw.
Iedereen maakt verlies en rouw mee in zijn leven. Vaak is het zoeken naar een manier hoe hiermee om te gaan. Nadat je iemand bent verloren, kan het leven aan de ene kant stilstaan en tegelijkertijd aan de andere kant doorgaan. Je moet je leven weer opnieuw oppakken, maar dat kan behoorlijk moeilijk zijn. Het kan helpend zijn om meer te weten

over hoe een rouwproces in het algemeen werkt, om vervolgens je eigen proces in beeld te krijgen. Daarnaast is gebleken dat wanneer ‘gelijkgestemden’ in contact komen met elkaar, dit helpt om met eigen verdriet om te gaan.
Stichting Welzijn Brummen biedt deze contactgroep aan, waarbij je stilstaat bij ‘een eigen manier van omgaan met verlies’ en in contact
komt met mensen die ook te maken hebben (gehad) met het verlies van een dierbare. Door middel van deze groep creëert Stichting Welzijn Brummen een veilige omgeving waarin mensen hun hart kunnen luchten, steun kunnen geven en kunnen ontvangen en hun verdriet en zorgen kunnen delen. Dit gaat soms gepaard met een traan, maar zeker ook met een lach. Want dat is wat we uiteindelijk willen: het
verdriet overleven en met een (glim)lach verder kunnen gaan.
Eigen situatie
In de vier bijeenkomsten wordt uitgelegd hoe rouw en een rouwproces werken, met aandacht voor jouw eigen situatie. Je leert hoe je verlies kunt dragen, mee kunt nemen in jouw dagelijkse leven. Je leert het verlies niet te verwerken, maar je leert het verlies anders vast te houden. Na vier bijeenkomsten wordt met de groep al dan niet besloten om maandelijks met elkaar in contact te blijven via bijeenkomsten die in Plein 5 zullen plaatsvinden.
“Heb jij te maken (gehad) met het verlies van een dierbare, waar je (nog steeds) last van ervaart? Weet je niet hoe je verder moet? Wordt je
Poppenspel rond mooie vriendschap
ZUTPHEN - Op vrijdagochtend 8 maart is de volgende ontmoeting van Café Ouders & Co.
Belangstellenden zijn welkom van 9.00 tot 11.30 uur in wijkrestaurant Geweldig! van het Sint Elisabeth, Geweldigershoek 39 te Zutphen.
Feico Hajonides en Claudia Alberding spelen dan het verhaal over een eenzame ijsbeer en een vos. Er
TOYOTA
ontstaat een mooie vriendschap tussen de twee verschillende dieren. De ijsbeer mist alleen zijn eigen land waar hij vandaan komt. De vos besluit hem te gaan helpen. Dit poppenspel wordt gespeeld met twee gevilte dieren, en is voor jong en oud.
Café Ouders & Co is een initiatief van Stichting de Geboortenis, Wijkrestaurant Geweldig! en Naviva Kraamzorg. Het biedt een


gezellige en leerzame ontmoetingsplek voor zwangeren en ouders met een baby en/of jonge kinderen. Het uitgangspunt is dat ouders onder het genot van een kop koffie of thee elkaar ontmoeten, zodat ze van gedachten kunnen wisselen over het ouderschap en daarbij behorende ervaringen of vragen die ze tegenkomen, terwijl de kinderen met elkaar kunnen spelen. Naar behoefte worden er thema’s rond opvoeding en ontwikkeling
TOYOTA
van het kind of kinderactiviteiten georganiseerd. Er zijn steeds twee gastvrouwen aanwezig die de ouders ontvangen. Zij zijn zelf ook moeder en/of werkzaam in de ouder- en kindzorg.
Eén keer in de maand zijn ouders met hun baby en/ of kindjes van 09.00 tot 11.30 uur van harte welkom in Geweldig! Geplande thema’s of activiteiten gaan om 10.00 uur van start. Er is voor de kinderen speelgoed


verdriet niet minder? Wil je weten hoe anderen omgaan met verlies en verdriet? Voel je je eenzaam in je verdriet? Dan zijn deze workshops wellicht wel iets voor jou”, aldus de organisatie.
De bijeenkomsten vinden plaats in Plein 5, Graaf van Limburg Stirumplein 5 in Brummen op de volgende woensdagochtenden: 13 maart, 27 maart, 10 april, 24 april, telkens van 10.00 tot 11.30 uur. Deelname is gratis. “Heb je interesse? Stuur dan een e-mail naar: k.vanaalst@welzijnbrummen. nl. Karin zal telefonisch contact met je opnemen, om naar jouw verhaal en eventuele vragen te luisteren. Samen bespreken we of deelname voor jou passend is. Je mag ook bellen naar 0575-561988 (op woensdag en donderdag).”

aanwezig. De toegang is gratis en consumpties zijn voor eigen rekening. Voor meer informatie over themaochtenden/activiteiten, zie: www.geboortenis.nl/ cafe-ouders-co-incafe-geweldig/
TOYOTA
Afscheid van dominee Ek

BRUMMEN - Dominee Jan Ek van de Protestante Gemeente te Brummen neemt zondag 10 maart om 10.00 uur afscheid in een feestelijke dienst in de Pancratiuskerk. Dominee Ek startte als predikant in Brummen in 2001 en gaat nu met pensioen, in de kerk ‘emeritaat’ genoemd.
Ek is geboren en getogen in Almelo en is theologie gaan studeren in Utrecht. In 1982 is hij gehuwd met Dinanda en samen hebben ze drie kinderen gekregen. In 1986 is hij predikant geworden in Oosterzee, in 1991 in Makkum en in maart 2001 begon hij in Brummen.
Ter gelegenheid van het afscheid van ds. Ek en zijn vrouw worden vrijdag 8 maart vanaf 17.00 uur festiviteiten georganiseerd in de Pancratiuskerk. Er is vermaak met herinneringen ophalen, muziek, toespraakjes, verrassingen, een Jan-verhaal en een gezellig samenzijn.

TOYOTA


Toyota Wagenmaker APELDOORN | Steenbokstraat 3 DEVENTER | Solingenstraat 1 ZUTPHEN | Brinkhorst 7 Telefoon: 055 - 539 6666 Telefoon: 0570 - 510 666 Telefoon: 0575 - 572 020 Nú voor € 54.999,- excl. BTW Nú voor € 54.999,- excl. BTW Nú voor € 35.750,- excl. BTW Nú voor € 42.800,- excl. BTW Nú voor € 39.395,- excl. BTW Nú voor € 38.395,- excl. BTW Apeldoorn Emissie vrij 2025
PROACE ELECTRIC COOL SHUTTLE 8-PERSOONS 75KWH
PROFITEER VAN DIVERSE SUBSIDIEREGELINGEN
TOYOTA PROACE DUBBELE CABINE ELECTRIC PROF
PROACE ELECTRIC LIVE LONG WORKER INCL. NAVIGATIE
TOYOTA PROACE ELECTRIC WORKER COOL COMFORT INCL. AIRCO
PROACE ELECTRIC LIVE LONG WORKER INCL. NAVIGATIE
10 JAAR GARANTIE…. OOK OP DE BATTERIJ
PROACE ELECTRIC LONG WORKER LIVE INCL. NAVIGATIE
Unieke screening voor schimmelinfecties
Nederland krijgt een wereldwijd uniek screeningssysteem voor schimmelinfecties. Er wordt voornamelijk gevreesd voor een uitbraak van de zogenoemde Candida auris. Door het systeem kan snel worden gereageerd als schimmels zich verspreiden.
Het screeningssysteem komt voort uit een samenwerking tussen het Radboudumc en het RIVM.
“Met dit systeem zijn we straks voorbereid op een toename van gevaarlijke schimmels en kunnen we snel reageren bij verspreiding en uitbraken”, schrijft projectleider Eelco Meijer in een bericht op de website van het Radboudumc. Met de screening moet al vroeg duidelijk

worden welke gisten er rondgaan. “Daarvoor worden rioolwater en bestaande infecties onderzocht. Dat
is belangrijk, want infecties met gisten zoals Candida auris zijn bezig aan een opmars”, vertelt Meijer.
Er is wereldwijd een sterke toename van het aantal infecties. Ook in Europa wordt de schimmel veel
gezien, vooral in Italië, Spanje en Griekenland. In Nederland zijn enkele gevallen geregistreerd. “In ons land zijn door de goede infectiemaatregelen ernstige schimmelinfecties gelukkig nu nog zeldzaam. Het gaat om tientallen infecties per jaar”, zegt Meijer. Hoeveel het er precies zijn is niet duidelijk, doordat we nu nog geen goed screeningssysteem hebben. Candida auris is vaak ongevoelig voor antischimmelmiddelen. Daardoor is de infectie moeilijk te behandelen. Daarom roept wereldgezondheidsorganisatie WHO op tot actie. Met het nieuwe surveillancesysteem wordt Nederland het eerste land ter wereld dat kan screenen op schimmels.
Candida auris is een schimmelsoort waar mensen met een goed afweersysteem over het algemeen niet ziek van worden. Maar kwetsbare mensen, die bijvoorbeeld net een orgaantransplantatie hebben ondergaan, kunnen er wél ernstig ziek van worden. De schimmel kan oorontsteking of koorts veroorzaken, maar ook in de bloedbaan terechtkomen of organen kapotmaken. In die gevallen is een infectie vaak dodelijk. De schimmel verspreidt zich vooral in ziekenhuizen en verpleeghuizen. Dat kan via besmetting van de handen of medische instrumenten. In tegenstelling tot de meeste soorten schimmels kan Candida auris namelijk overleven buiten het lichaam.
Vrouwen hebben op lange termijn meer profijt van sporten dan mannen
Vrouwen die sporten, ervaren daar op de lange termijn meer gezondheidsvoordelen van dan mannen. Zo verkleint de kans op overlijden aan bepaalde oorzaken voor vrouwen met 24 procent, terwijl die bij actieve mannen met slechts 15 procent daalt.
Bovendien hoeven vrouwen daar minder voor te doen dan mannen, blijkt uit nieuw Amerikaans onderzoek van het Schmidt Heart Institute waaraan 400.000 mensen deelnamen. De vrouwelijke deelnemers deden wekelijks aanzienlijk minder
aan lichaamsbeweging en krachttraining dan de deelnemende mannen. De bevindingen suggereren dat mannen en vrouwen niet evenveel hoeven te sporten om te profiteren van de voordelen van lichaamsbeweging voor hun levensverwachting. Mannen moesten vijf uur cardiotraining per week doen voor de maximale gezondheidsvoordelen. Vrouwen profiteerden al van diezelfde voordelen met iets meer dan twee uur matige tot krachtige cardio per week. Met krachttraining profiteerden mannen pas optimaal
GEUREN EN KLEUREN
In onze taal wordt de naam thee vaak gebruikt voor aftreksels van theebladeren en allerlei kruidenbladeren. Maar puur gezien leidt het gebruik van kruidenbladeren niet tot een pot thee. Wat is het verschil en waarmee kan het assortiment van De Stoelendans u een dienst bewijzen. Lees verder en misschien brengen onze kruiden een spectrum van geuren en kleuren bij jou thuis.
Thee is een warme drank die wordt gemaakt door infusie (thee) van de gedroogde bladeren van de theeplant Camellia sinensis. Vaak worden diverse kruiden of delen van planten al dan niet in verse vorm als ‘thee’ gezet, maar deze zijn eigenlijk geen thee maar een tisane. Tisane of kruidenthee is een op thee lijkende warme drank die gemaakt wordt van diverse kruiden. Omdat kruidenthee geen thee bevat, bevat de drank geen cafeïne of looizuur. Mensen die gevoelig zijn voor deze stoffen kunnen veel kruidenvarianten voor het slapen gaan drinken zonder inslaapproblemen te krijgen.
Kruiden en gezondheid
Een kruid is een plant die gebruikt wordt in de traditionele geneeskunde en andere gebieden die te maken hebben met gezondheid en welzijn, zoals aromatherapie. Veel kruiden kennen een lange geschiedenis van medicinaal gebruik. Kruiden en planten zijn vaak zeer zachtaardig en kunnen worden gebruikt om een breed scala aan aandoeningen en kwalen te behandelen,
na drie sessies per week. Terwijl vrouwen dezelfde winst behaalden met slechts één sessie per week.
One size fits all-benadering misschien niet meer geschikt
Onderzoekers weten niet zeker wat deze verschillen veroorzaakt. Maar een aannemelijke verklaring is dat vrouwen relatief meer vet in hun lichaam hebben, waardoor hun aderen beter kunnen uitzetten als dat nodig is. Daardoor kan er meer bloed naar de spieren. Toch wordt ook een kanttekening geplaatst: het onderzoek
houdt geen rekening met de mate van intensiteit. Bij bepaalde taken is de fysieke inspanning bij vrouwen hoger dan bij mannen. Het zou dus kunnen dat vrouwen minder vaak hoeven te bewegen doordat ze zich per keer meer inspannen.
De resultaten van dit onderzoek suggereren dat de aanbevelingen voor lichaamsbeweging per geslacht zouden moeten verschillen. Vrouwen profiteren immers sneller van beweging dan mannen. Hoewel meer onderzoek deze bevindingen moet

bevestigen, denken wetenschappers dat het tijd is om af te zien van een one size fits all-benadering van de lichamelijke gezondheid. Cardiologen hopen
dat dit onderzoek vrouwen aanspoort om regelmatig te bewegen, aangezien zij daarmee duidelijk investeren in hun gezondheid voor de langere termijn.

zelfs bij mensen die bijzonder gevoelig zijn voor behandelingen of medicijnen. Modern onderzoek heeft ertoe geleid dat veel mensen de voordelen onderzoeken van het gebruik van kruiden voor de behandeling van een reeks aandoeningen. Kruiden hebben weinig bijwerkingen en zijn over het algemeen zeer veilig in het gebruik, maar let op, er zijn uitzonderingen. Goed onderzoek vooraf is wel een vereiste.
Uitgebreid kruidenassortiment
De Stoelendans heeft een uitgebreid kruidenassortiment. Voor zover de kruiden, volgens wettelijke richtlijnen, ingedeeld kunnen worden, zijn deze opgenomen in de categorieën concentratie, energie, slaap en ontspanning, spijsvertering en detox, sexualiteit en psycedelica. Niet alle kruiden uit ons assortiment staan op de website. Dit heeft te maken met wettelijke richtlijnen. Dus wanneer je op zoek bent naar een specifieke soort neem dan even contact op. De categorie theekruiden is onlangs uitgebreid met 3 nieuwe varianten. Kruidenmengsels uit Brazilië met een activerende werking, één met rust bevorderende werking en een mix van wilde bloemen, gewoon omdat deze lekker is.
Van vitaliserend tot hallucinogeen
Al jaren volgen Alexandra en Ida bijscholingen op het gebied van vitaliserende paddenstoelen. Veel mensen hebben inmiddels de positieve werking van deze paddenstoelen op hun gezondheid ervaren. Op het gebied van de hallucinogeen werkende truffels heeft
het tweetal inmiddels kennis over de brede inzetbaarheid van microdosering. Met het toepassen van een energetische test kan zeer precies advies gegeven worden over het juiste product.
Wierook
In de hersenen verwerken we geur in hetzelfde gebied als emoties. Daardoor is onze reukzin nog meer dan andere zintuigen met emotie verbonden. Onze reukzin heeft grote invloed op de manier waarop we de wereld om ons heen beleven. Geuren kunnen invloed hebben op onze gemoedstoestand, oude herinneringen oproepen en zelfs de band met geliefden versterken. Geurige bloemen, kruiden en planten worden al duizenden jaren ingezet om genezing te bevorderen. Door het branden van een wierook kan de stemming, het stressniveau en de cognitieve functie worden beïnvloed.
Kom eens langs in onze winkel en laat oude herinneringen herleven of creëer nieuwe herinneringen.
Zorg & Welzijn 10
De-Stoelendans.nl • Nieuwstraat 53 • 7411 LH Deventer Volg en like ons op: facebook.com/De.Stoelendans
ONZE NIEUWE KRUIDEN (THEESOORTEN) BRENGEN
Vijf vragen over het vaccin tegen het RS-virus

De Gezondheidsraad kwam onlangs met het advies om alle baby’s met een vaccinatie te beschermen tegen het RS-virus. Wat is het voor virus? Hoe werkt de vaccinatie en wat zijn de bijwerkingen?
1. Wat is het RS-virus en hoeveel kinderen hebben er last van?
Het respiratoir syncytieel virus (RSV) is het meest voorkomende verkoudheidsvirus bij kinderen. Bijna alle kinderen hebben voor hun tweede levensjaar een infectie gehad met het virus, dat vooral in de wintermaanden voorkomt. De meeste kinderen worden er alleen

verkouden van, maar bij baby’s kan het RS-virus zorgen voor bronchiolitis of longontsteking, schrijft het RIVM. Kinderen die te vroeg geboren zijn, met het syndroom van Down of een aangeboren hartafwijking, lopen meer risico om ernstig ziek te worden.
Eén tot twee procent van de baby’s (tot 1 jaar) wordt vanwege het RS-virus opgenomen in het ziekenhuis, zegt het RIVM. Een deel van hen moet zelfs naar de intensive care. De meeste ziekenhuispatiëntjes waren gezond voordat ze de infectie kregen. De kans op overlijden aan het RS-virus is in
Nederland heel erg klein. In landen waar een gebrek is aan medische zorg, is de kans op overlijden groter.
2. Welke opties voor een vaccinatie zijn er? Kinderen die een verhoogd risico lopen, krijgen een zogeheten ‘passieve vaccinatie’, zegt het RIVM. Zij kregen het medicijn palivizumab via een prik, die tijdens het RSV-seizoen elke maand herhaald moet worden. Het medicijn werkt namelijk maar voor vier weken.
In het advies van de Gezondheidsraad gaat het om een nieuwe antistof die recent op de

Verende steunzolen
Op maat gemaakt
Past in alle soorten schoenen
Optimale drukverdeling
De steunzolen gaan 5 jaar lang mee
Of vraag voor meer informatie onze gratis brochure aan via:







Gratis en vrijblijvend advies aan huis. Bel naar: 053 - 82 00 810
"Slechts 1 mm dik"
www.fusselastic.nl
markt is gekomen: nirsevimab. Het middel staat bij het Europese geneesmiddelenbureau (EMA) geregistreerd als medicijn dat voor alle baby’s gebruikt mag worden en niet alleen voor risicogroepen. Als een zwangere vrouw voor de geboorte van haar kind wordt gevaccineerd, maakt ze antistoffen aan en geeft ze die door aan de foetus. Volgens de Gezondheidsraad is het erg belangrijk dat dit minstens twee weken voor de bevalling gebeurt. Een andere mogelijkheid is om een baby in het eerste levensjaar antistoffen toe te dienen via een prik.
3. Hoe snel en hoelang is een baby beschermd na vaccinatie?
Bij het toedienen van het vaccin via de moeder hebben de antistoffen twee weken de tijd nodig om te werken voor het kind, schrijft de Gezondheidsraad. Als de antistoffen via het vaccin direct worden toegediend aan de baby, is de baby direct beschermd.
Nirsevimab biedt minstens vijf maanden bescherming. Daarom is één prik per RSVseizoen genoeg om een baby te behoeden voor een ernstige infectie. Voor het effect van het vaccin is het wel belangrijk om te kijken wanneer dat wordt toegediend. Stel: een moeder
bevalt na het virusseizoen, dan is het niet zo zinvol om het vaccin via de moeder te geven. Het werkt dan namelijk maar voor zes maanden en dan is de effectiviteit tegen de tijd dat het virus rondwaart alweer afgenomen.
Datzelfde geldt eigenlijk voor de tweede optie: het direct vaccineren van de baby. De Gezondheidsraad adviseert om kinderen die vlak voor of tijdens het RSVseizoen worden geboren het middel direct na de geboorte aan te bieden, of op z’n minst binnen twee weken. Kinderen die na het RSVseizoen worden geboren, kunnen de prik het beste vlak voor het begin van het nieuwe RSV-seizoen krijgen. Dat is meestal oktober. De Gezondheidsraad heeft daarom de voorkeur om antistoffen direct toe te dienen aan kinderen, zodat ze zo goed mogelijk beschermd zijn tegen het virus.
4. Wat zijn de bijwerkingen van het vaccin?
Als er voor een vaccinatie via de moeder wordt gekozen, zijn de bijwerkingen volgens de Gezondheidsraad over het algemeen mild en van korte duur. Er wordt nog wel onderzoek gedaan naar een ‘potentieel licht verhoogd risico’ op vroeggeboorte.
Ook bij kinderen is de kans op bijwerkingen klein. Het
JE HORMONEN IN BALANS.
D a a r g a a n w e v o o r !
Eenkrachtige,tteenenergiekevrouw. Zowiljijjevoelen.Nietaltijdisdatzo.
Herken jij hier iets van?
Je voelt je vaak moe of neerslachtig
Je zou graag meer energie willen hebben
Je hebt menstruatieklachten
Je wilt je t voelen voor tijdens en na je zwangerschap.
Ik bied hulp bij: Menstruatieklachten Een kinderwens
Je t voelen ook in je zwangerschap
EMA geeft het voorbeeld van een rode of pijnlijke plek op de plaats van de vaccinatie of koorts, maar dat is niet heel anders dan bij andere vaccinaties. In beide gevallen zegt de Gezondheidsraad dat de gezondheidsvoordelen opwegen tegen die kleine kans.
In Spanje wordt er al gevaccineerd en daar is bij meer dan zevenduizend vaccinaties nog geen sprake geweest van ernstige bijwerkingen, zegt de raad.
5. Hoe snel wordt de vaccinatie opgenomen in het Rijksvaccinatieprogramma?
De Gezondheidsraad heeft het advies gegeven om het RS-virus zo snel mogelijk in het Rijksvaccinatieprogramma te laten opnemen. Dat schreef de raad in een brief aan demissionair staatssecretaris Maarten van Ooijen van Volksgezondheid. Het is nu dan ook aan het kabinet om het advies wel of niet over te nemen.
Van Ooijen heeft direct na het advies al laten weten dat er op dit moment geen geld is om het advies uit te voeren. “Voor meerdere positieve vaccinatieadviezen van de Gezondheidsraad geldt dat er geen financiering beschikbaar is”, laat hij weten. Een volgend kabinet zal hierover een besluit moeten nemen.



Je hebt een kinderwens









Klachten voor, tijdens of na je zwangerschap Herstellen van je hormoonbalans Anticonceptiekeuze

Vraag het magazine gratis aan!


Je hebt huidklachten zoals eczeem of acné


Willemijn Dijkman- Eshuis Hormoondeskundige | Verloskundige













trombosestichting.nl/magazine

“Ik heb de overtuiging dat door leefstijlverandering, op een zo natuurlijk mogelijke manier, veel klachten kunnen verminderen of verholpen kunnen worden”.
Ikhelpjegraag!
Woonzorgvoorziening/zorghotel De Gouden Leeuw Zutphen komt graag in contact met Zorgmedewerkers. Het volgen van een opleiding tot zorgmedewerker, van VIG tot VPK behoort tot de mogelijkheden.
Stuur een reactie naar: personeelszaken@degoudenleeuwgroep.nl of zoek telefonisch contact 0314-628200 en vraag naar personeelszaken.
Clercqstraat 58 Zutphen, linker toren

www.degoudenleeuwzutphen.nl



Zorg & Welzijn 11
De
CONTACT 0 6 - 4 2 4 9 5 4 8 4 w i l l e m i j n @ p r a k t i j k a l e i d e . n l f w w w . p r a k t i j k a l e i d e . n l
EXPERTISE IN HORMOONBALANS PRAKTIJK



E en nieuw th u is bij woonzorgcentr um Polbeek in Zu tphen
Verh u izen n aar een woon zorgcentrum is een in grijpende stap Het bek en de en vertrou wde van th u is maak t plaats voor iets on bekends en n ieu ws Samen met u w soc iale n etwerk doen on ze medewerk ers en vrijwilligers er alles aan om u snel dat echte thuisgevoel te geven en ben t u van h arte welk om om u w leven te delen
Woonzorgcentrum Polbeek is een markant gebouw in Zutphen waar we werken vanuit ons hart Op deze locatie bieden we intramurale zorg aan ouderen met een somatische of psychogeriatrische zorgvraag. Daarnaast leveren we thuiszorg aan bewoners van de huurappartementen en de naastgelegen aanleunwoningen. Onze ruime zorgappartementen zijn ook heel geschikt voor echtparen.
In de Polbeek zijn onder andere een restaurant, huisartsenpraktijk, fysiotherapeut, apotheek, kapper en kinderdagverblijf aanwezig.
Ben ieuwd n aar u w mogelijkheden?
Neem dan contact op met een van onze clientadviseurs. We staan u graag te woord. T. 0575 –498 498
Zie ook: www.zorggroepsintmaarten.nl/polbeek
De functie:
De begeleider begeleidt en ondersteunt de bewoners in hun dagelijkse leven. We werken volgens het KlipperZorg-model.
Je taken:
• Je geeft uitvoering aan enkele persoonlijk begeleiderschappen
• Je kan doelstellingen van bewoners vertalen naar de praktijk van alle dag
• Het onderhouden en versterken van het netwerk van de bewoner
• Het verzorgen van individuele en groepsgerichte begeleiding
• Je draagt zorg voor de juiste veiligheid binnen de locatie en neemt zo nodig maatregelen ter voorkoming van onveilige situaties
• Het uitvoeren van specifieke ondersteunende taken ten behoeve van het functioneren van het team

Kinderen met antibiotica kunnen eerder naar huis

ZUTPHEN - In Gelre ziekenhuizen worden kinderen behandeld die langdurig antibiotica nodig hebben. Dat gebeurt via een infuus. Gelre ziekenhuizen en KinderThuisZorg Nederland hebben met elkaar het zorgtraject nog verder geoptimaliseerd om deze zorg soepel en veilig naar de thuissituatie te verplaatsen.
Dr. Schuurman, kinderarts in Gelre ziekenhuizen: “Bij een kind dat langdurig antibiotica nodig heeft, maken we altijd de afweging tussen wat moet in het ziekenhuis en wat kan in de thuissituatie. Het uitgewerkte zorgpad geeft nog meer duidelijkheid, uniformiteit, stroomlijning en veiligheid in dit proces. De nauwere samenwerking met KinderThuisZorg
maakt de overstap naar thuis nog kleiner. Met als doel dat we de benodigde zorg zo veel mogelijk kunnen leveren in de meest vertrouwde omgeving van het kind. ”Ook voor ouders is het fijn wanneer de zorg thuis kan plaatsvinden.
Iris Maartense, kinderverpleegkundige bij KinderThuisZorg: “Wanneer het kind medisch gezien niet meer in het ziekenhuis hoeft te verblijven, is er niks mooier om samen met kind en gezin te kijken naar wat zij nodig hebben om de (be)handeling naar huis te verplaatsen. Door de krachten van ons en het ziekenhuis te bundelen, is het mogelijk om de infuustherapie die in het ziekenhuis wordt opgestart, zo snel mogelijk thuis te vervolgen. Dat betekent zo min mogelijk
onderbreking van de ontwikkeling en zo kan het normale leven doorgaan in de veilige omgeving van het kind. Zorg in het ziekenhuis als het nodig is, thuis als het kan.”
De Juiste Zorg op De Juiste Plek
“We zijn blij met deze mooie samenwerking, die we met elkaar verder hebben uitgebouwd. Dit sluit aan bij de strategie van Gelre ziekenhuizen om waar mogelijk ziekenhuiszorg naar huis of een wijklocatie te verplaatsen, samen met andere zorgorganisaties, zoals KinderThuisZorg. Het past ook bij het streven van de overheid naar De Juiste Zorg op De Juiste Plek, waarin patiënten passende en kwalitatief hoogwaardige zorg op maat krijgen.”
Goedschalige zorg waarin je gezien en gehoord wordt
De Klipper Zorg biedt aan mensen met een lichte verstandelijke beperking 24-uurs zorg en ondersteuning. De Klipper Zorg werkt aan de ontwikkeling van bewoners, met als doel dat zij zoveel als mogelijk zelf de regie hebben en zo zelfstandig mogelijk kunnen functioneren. De kwaliteit van leven staat voorop! De Klipper Zorg streeft naar zinvolle dagbesteding voor alle bewoners. Op alle locaties wordt dagelijks samen met de bewoners gekookt. Plezier is voor ons een belangrijk werkwoord De Klipper Zorg heeft 3 begeleidingslocaties in Zutphen waar meerdere mensen met elkaar samenwonen. We staan midden in de samenleving en maken een mooie groei door omdat bewoners en verwanten ons weten te vinden. We zijn op zoek naar versterking van ons team op het Reesink. We hebben plek voor een inhoudelijk en professionele,
28 uur
• Je werkt mee in groep-(24 uur) en individuele dienstverlening
• Het stimuleren en motiveren van teamleden door middel van het geven en ontvangen van feedback
• Het verrichten van voorkomende werkzaamheden.
Wij verwachten van jou dat je:
• Een afgeronde passende pedagogische of verpleegkundige opleiding hebt op minimaal MBO-niveau 4, bij voorkeur aangevuld met enkele jaren werkervaring met de doelgroep;
• Een stevige persoonlijkheid hebt met een mensgerichte werkhouding, waarbij je inspeelt op de hulpvraag van de individuele bewoner;
• Een positieve bijdrage kunt leveren aan de ontwikkeling van het team;
• Beschikt over goede mondelinge en schriftelijke uitdrukkingsvaardigheden;

• Beschikt over sociale vaardigheden als tact, inlevingsvermogen en een relativerend vermogen, daarnaast heb je een flexibele werkhouding;
• Onvoorwaardelijke ondersteuning biedt aan de bewoners.
Wat kan jij van ons verwachten:
• Een dynamische functie in een collegiaal team;
• Een prettige werksfeer waarin eigen initiatief en creativiteit worden gewaardeerd;
• Ruimte om mede richting te geven aan de ontwikkeling van het beleid en ontwikkeling van De Klipper Zorg;
• Een organisatie die gaat voor kansen en mogelijkheden van bewoners en medewerkers
• Salaris conform CAO- gehandicaptenzorg FWG 40;
• Een aantal aantrekkelijke secundaire arbeidsvoorwaarden.
Nadere inlichtingen kun je verkrijgen bij
Adrie Kemper eindverantwoordelijk 06-54272422 of Anke Simonis locatie coördinator 06-30337127
Solliciteren kan uiterlijk tot en met maart 2024 door een mail te sturen naar: akemper@deklipperzorg.nl

24 uurs zorg goedschalig dagbesteding in huis
dienstverband
Begeleider (m/v)
TROELSTRALAAN Troelstralaan 1, 7204 LC Zutphen LEEUWERIKSTRAAT Leeuwerikstraat 2, 7203 JC Zutphen ‘T
4, 7202 DJ
De Klipper Zorg Troelstralaan 1 7204 LC Zutphen akemper@deklipperzorg.nl De gesprekken zullen donderdag 21 maart plaatsvinden. 12
REESINK Reesinkhof
Zutphen
Zorg & Welzijn
OP GROTE SCHAAL GEVOEL VAN ONVEILIGHEID, DEPRESSIES EN ANGSTEN
Eén op de drie mensen met gehoorverlies ervaart fade-out

De impact van gehoorverlies op het welzijn van ruim 1,5 miljoen Nederlanders is groot. Eén op de drie ervaart fade-out: mentale problemen waarbij zij sociaal steeds verder naar de achtergrond raken. Een groot deel van mensen die fade-out ervaart voelt zich onveilig (46%), depressief (47%) en angstig (43%). 51% geeft zelfs aan de grip op het leven te verliezen. Dit blijkt uit nieuw onderzoek, uitgevoerd door Motivaction ter gelegenheid van World Hearing Day op zondag 3 maart.
De focus bij gehoorverlies ligt vaak op het oplossen van het fysieke probleem. Het mentale aspect van gehoorverlies wordt vaak nog onderbelicht of genegeerd. Terwijl de gevolgen voor het mentale welzijn enorm zijn, blijkt uit dit onderzoek. “In Nederland zijn 500.000 mensen met gehoorverlies die fade-out ervaren. Kenmerkend voor
deze groep mensen is dat zij sociaal gezien vaak langzaam naar de achtergrond raken. Sociale contacten worden minder en de kans op eenzaamheid neemt toe. Met het risico om in een sociaal isolement te raken”, aldus Eric Schoenmakers, senior onderzoeker op het gebied van eenzaamheid. Fade-out is een fenomeen dat zich vaak stil en
onzichtbaar voor de omgeving afspeelt. Daarom is het zo belangrijk dat hier naam aan wordt gegeven. Dat zorgt voor erkenning. Want pas als je iets benoemt, wordt het tastbaar en kun je er iets aan doen.
Schaamte en onzekerheid Uit het onderzoek komt naar voren dat 39 procent van alle mensen die gehoorverlies


Jij bent een kei!
ervaren maar geen hoortoestel dragen, hier al langer dan vijf jaar mee rondloopt. 44 procent van hen heeft het gehoorverlies ook nog nooit laten onderzoeken door een hoorspecialist of een huisarts. Het fysieke probleem wordt dus vaak niet direct erkend, laat staan de mentale klachten die hiermee gepaard gaan. “Mensen vragen lang niet altijd hulp. Toch blijkt uit het onderzoek dat mensen wel behoefte hebben aan mentale zorg en ondersteuning en deze niet altijd krijgen. Een hoortoestel alleen is vaak onvoldoende om met de fysieke, emotionele en sociale uitdagingen, waarmee slechthorenden te maken hebben, om te gaan. Het bieden van handvatten is voor mensen met gehoorverlies van essentieel belang om sociaal weer te kunnen participeren, en om gezond en gelukkig te leven”, stelt Saïd Bellari, psychiater en geneesheer-directeur bij GGMD. Het onderzoek laat zien dat gehoorverlies van invloed is op de mate van geluk. 38 procent voelt zich minder gelukkig vanwege gehoorverlies. Ook ervaren mensen onzekerheid (44%) en schaamte (32%), wat mogelijk een rol speelt bij het negeren van de klachten.
Jongeren ervaren vaker fade-out Het onderzoek laat zien dat

leeftijd een belangrijke factor is in de mate waarin mensen met gehoorverlies fadeout ervaren. Jongeren (18-24 jaar) ervaren een stuk vaker (59%) fade-out dan mensen van 45 jaar en ouder (2330%). Een verklaring hiervoor moet volgens prof. dr. Gert-Jan Hendriks, Radboud Universiteit, gezocht worden in de sociale relaties en levensfase van de verschillende groepen. “Fadeout gaat over hoe je je voelt in een sociale context. Jongeren staan midden in het leven, hebben vaak veel sociale contacten en willen graag overal aan meedoen. Sociaal niet (meer) kunnen meedoen heeft bij hen een nog grotere impact op hun mentale welzijn.”
Sociaal experiment
Dagelijks ervaren ruim
500.000 Nederlanders fadeout. Dit gaat gepaard met onder andere regelmatig
gesprekken met familie, vrienden en collega’s niet kunnen volgen. Hierdoor verdwijnen zij langzaam naar de achtergrond en vermijden zij ook geregeld sociale activiteiten. Drie van de vijf mensen met gehoorverlies geven aan dat hun verminderd gehoor belemmerend werkt in het dagelijks leven. Om voor dit issue aandacht te vragen is er in samenwerking met cabaretier en ervaringsdeskundige Kees van Amstel een sociaal experiment opgezet. Een avondje lachen in het theater met Kees van Amstel, waar niet alle grappen even goed te volgen waren. Tijdens deze avond zijn drie proefpersonen uitgenodigd die hebben ervaren hoe het is om de ‘grap’ niet te volgen, en om dus te ervaren hoe het is als je als enige niet begrijpt waarom er gelachen wordt. Iets wat veel Nederlanders dagelijks ervaren door hun gehoorverlies.

Mensen zijn keien in problemen oplossen. Lukt iets niet, dan bedenken we wel iets zodat het wel lukt. Soms gaat het zelf oplossen niet zo gemakkelijk. Je merkt bijvoorbeeld dat je in dezelfde denkcirkel blijft denken. Je loopt steeds weer tegen dezelfde situaties aan in je relatie of op je werk. Of misschien wil je graag verandering in je leven, maar krijg je het niet voor elkaar. Je blijft maar staan op het punt waar je staat. Een coach kan helpen om die cirkels te doorbreken. Ik ben gecerti ceerd NOBCO-coach en werk met verschillende methodieken, materialen en oefeningen. De Transactionele Analyse is een prachtige en praktische ziens- en denkwijze en vormt de basis van de coachingsgesprekken.



De coaching is gericht op het inzicht krijgen in jouw patronen en manieren van denken en doen. Hierdoor ga je herkennen wat er bij jou van binnen gebeurt en vooral hoe jij het anders kunt doen. Oefening baart kunst, ook thuis werk je aan opdrachten die je een stap verder helpen. Coaching is tijdelijk, want natuurlijk kun jij het alleen! Jij bent een kei!
Wil jij:
• Steviger in je schoenen komen te staan?;
• (Een andere) richting geven aan je loopbaan?; (ook UWV trajecten)
• Beter weten wat je wilt en daar voor gaan staan?;
• Negatieve gedachten de baas worden?
Maak dan een gratis kennismakingsgesprek, ik ben nieuwsgierig naar jouw verhaal!
Zorg & Welzijn 13
KEI COACHING EN TRAINING www.keicoachingentraining.nl | info@keicoachingentraining.nl | Tel.: 06-24225098
COLOFON
Postbus 638, 7300 AP Apeldoorn Kantoor, redactie en administratie: Asselsestraat 140, 7311 ET Apeldoorn. Tel. 055 - 5219878 verkoop@stedendriehoek.nl redactie@stedendriehoek.nl www.stedendriehoek.nl
Klachten bezorging: 055 - 303 4901 klachten@stedendriehoek.nl
Volg ons ook op:
M N S V P
Sluitingstijd advertenties: maandagmorgen 12.00 uur Redactie: vrijdag 17.00 uur voor de week van verschijning Advertentieverkoop: tijdens kantooruren 09.00-17.00 uur.
Acquisitie: Jacqueline Boekema, John Ruisch, Sacha van Beers, John Herbrink
Hoofdredactie: Marc Looijen, Elisa De Bruijn
Social Media
Sieb Hogewerf
Vormgeving: André Mos, Jack Willemsen
Administratie: Suzanne Boekema-van Buijsen
Opgave rubrieksadvertenties (3-hoekjes) Apeldoorn: Kantoor Asselsestraat 140 of via: www.stedendriehoek.nl
Uitgave van Uitgeverij
Stedendriehoek B.V.
Directie:
J. Boekema, F. Boekema
Oprichter: J.P.S. Boekema



ADVERTEREN? bel 055-5219878
Nieuwsblad Stedendriehoek
Elke week in uw brievenbus | Iedere dag online!
www.stedendriehoek.nl
OP ZOEK NAAR EEN DUURZAME RELATIE?
Al eens aan persoonlijke bemiddeling gedacht ?
Veilig en betrouwbaar
Wij zoeken iemand die bij u past.
POSTZEGELS, MUNTEN, ZILVER & GOUD; GRATIS TAXEREN VOOR VERKOOP BIJ
T.G. Gibsonstraat 17 - Deventer - 0570 831255 - www.hetinkoopkantoor.nl
VLOOIENMARKTEN
ZATERDAG 16 MAART
ROMMELMARKT ACHILLES
09:00 tot 13:00 uur. Tel.: 06-51800646
Ln. van Kerschoten 12 Apeldoorn. huisraad-speelgoed-boekenelec.app.-keuken spullen-brocante-meubels-boeken.
VACATURES
DIVERSEN
BAK VAN DE WEEK
Fredje zit te huilen bij de beek. Een meneer vraagt: ‘Wat is er jongen?’ ‘Ze hebben mijn boterham in de beek gegooid!
‘Met opzet?’ ’Nee met kaas’
Vijf euro verdienen? Stuur je mop onder vermelding van je naam en bankrekeningnummer naar redactie@stedendriehoek.nl

Maak kans op 2 entree-kaarten

WEEKENDDIENSTEN
APELDOORN
Huisartsen: Spoedgevallen
085-0791110.
Apotheken: Gelre Lukas.
Spoedrecept. ma.-vrij. 17.30-24.00 za./zo./ feestdagen 08.00-24.00.
Na 24.00 uur, telefoon 055-5811840.
Tandartsen: weekend tel. 085-0189466.
Dierenartsen: Bel uw eigen dierenarts Medifoon Apeldoorn: weekend 0900-55.555.555 (100 cpm)
DEVENTER
Apotheken: Apotheek Salland, 24 u. centrale hal Deventer Ziekenhuis, Nico Bolkesteinlaan 75, telefoon 0570-536505.
Huisartsen: voor spoed telefoon 0570-501777.
Tandartsen: Dental365
Spoed Tandarts Deventer
Noodtandarts, Avond & Weekend Tandarts telefoon 085-0189466.
Dierenartsenpraktijk: Keizerslanden, Graaf Florisstr. 1b, telefoon: 0570-622288.
TWELLO:
Dierenkliniek Twello B.V Molenstraat 49, Twello, telefoon: 0571-272624
GROOT COLMSCHATE
Huisartsen: Centraal telefoon: 0570-501777. Regio Dierenambulance 0900-9991999 (45 eurocent).
VOORST-KLARENBEEK
Dierenartsen: De Driehoek, telefoon: 055-3012255.
ZUTPHEN:
Huisartsenpost Zutphen: telefoon: 0900-2009000, werkdagen 17.00-08.00 uur, weekend 24 uur bereikbaar.
Apotheken: Dienstapotheek Gelre Apotheek Zutphen, Den Elterweg 77, telefoon: 0575-744800.
Tandartsenkring Zutphen e.o.
Spoedgevallen weekend telefoon: 0575-512288.
Dierenartsen: De Graafschap Dierenartsen, 24-uurs dienstverlening, telefoon: 0575-587880.
WARNSVELD
Homeopathie praktijk: zaterdag 10.00-12.00 uur en op afspraak via telefoon: 0575-573103.
Consulent blijft de contactpersoon Single coaching mogelijk www.hetrelatiebureau.nl info@hetrelatiebureau.nl tel.: 085 - 0765 365
BIJLESDOCENTEN/ STUDENTEN GEZOCHT; bijles aan huis Voor wiskunde en andere exacte vakken, regio Deventer ABACUS Bijlesinstituu. Tel.: 06-52332220 www.abacus-bijlessen.nl/s. husken@abacus-bijlessen.nl

HUWELIJK & KENNISMAKING
St. Stap organiseert extra avond om te dansen.
Zaterdag 9 maart 2024 dansen met muziek van
BACKLIGHT
Café & Zalencentrum Mulder, Gramsbergerweg 68 7772 PB HARDENBERG. Zaal open vanaf 19.30 uur. Info tel.: 06-51157422 www.stichtingstapswingt.nl
St. Stap organiseert zondag 10 maart 2024 dansen met muziek van DUO TOTAAL
Café-Restaurant WITKAMP, Dorpstraat 8 LAREN ( GLD ). Zaal open vanaf 19.30 uur. Info tel.: 06-51157422 www.stichtingstapswingt.nl
ONTSPANNING
Vrijdag 15 maart
Apeldoorn, gebouw DCA, Pr. Beatrixlaan 240. Avond Numerologie met Nicole van Olderen. Inzichten op je levenspad. Aanvang 20.00 tot 21.30 uur. Toegang € 12,50. Informatie: nickysplace.nl of bel Nicole 06-41041509.
IN-/VERKOOP!
Oud goud = Hoogste prijs
Hoofdstraat 65, Apeldoorn Burchtstraat 57, Nijmegen
WERK AANGEBODEN
Gepensioneerde aannemer/installateur voor: - aanpassingen meterkast - storingen/installatie - vervangen sloten - bouwbegeleiding. Tel.: 06-53117570.
Gepensioneerde elektriciën, ook voor andere bijkomende klusjes in Apeldoorn e.o. Tel.: 06-53316694
GROTE VLOOIENMARKT ZELHEM
ZONDAG 25 FEBR. 9-16 uur SPORTHAL DE POL
Vincent van Goghstraat 72 Info Kr.Huur 06-39108152 www.animo-vlooienmarkten.nl
WONINGRUIL
Jij naar Deventer? Wij naar Apeldoorn! Interesse in woningruil? 2 slaapkamers, tuin, eigen oprit in een rustige buurt vlakbij scholen, winkelcentrum en station. Ik ben op zoek naar in ieder geval 3 slaapkamers! Mail naar ruilenapde@gmail.com.
GEZONDHEID
Pauliens
Pedicure Praktijk
06-1566 5910
Voetzorg bij u thuis. Deventer Noord, Colmschate. € 35,00 basisbehandeling. Gecertificeerd en lid van ProVoet.
TE HUUR
AANGEBODEN
APPARTEMENT TE HUUR
Nieuwstad 21, Zutphen Prijs inclusief stook-, serviceen internetkosten 845 euro. Contact, tel.: 06-16612555.
BEZORGING KRANT NIET GOED
Mail dan naar klachten@stedendriehoek.nl of via de website: www.stedendriehoek.nl
Gevraagd: oud ijzer, accu’s, metalen en witgoed. Wij komen het bij u halen. Eventueel tegen kleine vergoeding. Tel.: 06-14101933.
SCHILDERWERK
SCHILDERBEDRIJF. GEBR.BOUWMEESTER
vragen schilderwerk. Buiten- & binnenschilderwerk. Sauswerkzaamheden. Vrijblijvende prijsopgave. Laagste prijs garantie. Garantie op de werkzaamheden. Tel.: 06-47602910.
STOFFEREN STOFFEERDERIJ
JOHAN
Stuur uw oplossing voor 14 maart 2024 naar Uitgeverij Stedendriehoek, Asselsestraat 140, 7311 ET APELDOORN of per e-mail naar puzzel@stedendriehoek.nl
Naam: __________________________________________________________________
Straat + huisnr.: _________________________________________________________
Postcode: ______________________________________________________________
Plaats: _________________________________________________________________
MOTOREN
Jarenlange ervaring met het stofferen van al uw MEUBELEN, opvullen van KUSSEN en inkleuren van leer, biezen en rieten matten. BEL: 06-22926757. TUINEN
Maak kans op 2 entree-kaarten

Motorliefhebber zoekt motorfiets tot 1980. BMW, Honda, etc. Ook lang stilstaande. Tel.: 06-22571321.
Het bestraten van tuin, terras, oprit, terrein etc. en tuinaanleg, eventueel ook levering van alle materialen. Sinds 1966. Klomp, Tel.: 06-54973731.
27 JAAR
KRINGLOOP RE-SELL
Voor overtollig huisraad en inboedels ‘tegen betaling’. Wij verzorgen ook het correct leegruimen, schoonmaken en opleveren van uw woning of bedrijf.
Kringloop Re-Sell
Coenensparkstraat 36, 7202 AN ZUTPHEN Tel.: 06-12354175
CONTACTEN
NIEUW: Erectiemiddelen bestellen?
Anita bellen
Afhalen en bezorgen. Tel.: 06-29819997 of 06-20653798.


Stuur de gekleurde tekening voor 14 maart 2024 naar Uitgeverij Stedendriehoek, Asselsestraat 140, 7311 ET APELDOORN
Naam: ___________________________________________________Leeftijd: ____ jr.
Straat + huisnr.: _________________________________________________________
Postcode: _______________________________________________________________
Plaats: __________________________________________________________________
ZOEK DE 10 VERSCHILLEN


VROUWEN-EN-PANNENKOEKDAG
Deze week vieren we op 8 maart zowel de Internationale Vrouwendag als de Nationale Pannenkoekdag. Het iconische gerecht, bestaande uit slechts meel, ei, melk en wat zout, heeft vele internationale spin-offs gekregen .Van de Japanse okonomiyaki tot de Russische blini, beiden worden hartig belegd.Wat te denken van de Roemeense clătită, de Franse crêpe en de Marokkaanse baghrir? De Amerikaanse variant is eigenlijk de Nederlandse drie-in-de-pan maar dan overladen met ahornsiroop. Wie zich afvraagt of zo’n internationale vrouwendag nog nodig is, heeft meer met een pannenkoek gemeen dan verwacht.
14
AFHAALPUNTEN NIEUWSBLAD STEDENDRIEHOEK Uitgeverij Stedendriehoek Asselsestraat 140 7311 ET Apeldoorn Gelre Ziekenhuis Albert Schweitzerlaan 31 7334 DZ Apeldoorn Ten Teije Healthcenter Heemradenlaan 101 7329 BZ Apeldoorn Malkander Zwembad Dubbelbeek 56 7333 NJ Apeldoorn Esso Tankstation Deventerstraat 41, 7311 LV Apeldoorn Talma Borg Fortlaan 47 7325 ZE Apeldoorn Jumbo Eglantier De Eglantier 606 7329 DN Apeldoorn De Vischmarkt, WC ‘t Orden Laan van Orden 199 7312 KH Apeldoorn Lokaliteit Broodhuis Apeldoornseweg 16 7351 AB Hoenderloo VVV-kantoor Stuijvenburchstraat 36 6961 CW Eerbeek Bospark De Schaapskooi Centrumweg 5 8162 PT Epe Bakker v/d Wal Jolink Markt 9 8161 EE Epe VVV-kantoor Pastoor Somstraat 6 8162 AK Epe Supermarkt de Spar Vaassenseweg 12 8166 AV Emst Benzinestation Tellegen Hoofdweg 41 8166 AC Emst VVVkantoor Daam’s Molen Molenstraat 18 8171 CE Vaassen Albert Heijn Houtzagersstraat 6 8171 CW Vaassen Bibliotheek Twello Marktplein 11 7391 DH Twello Boekhandel Oonk Primera Stationsstraat 4 7391 EK Twello DZ - DeventerZiekenhuis Nico Bolkesteinlaan 75 7416 SE Deventer Bibliotheek Centrum Deventer Stromarkt 18 7411 PK Deventer Supermarkt Plus Beestenmarkt 3 7413 ZA Deventer Dirk van den Broek Dreef 150 7414 EJ Deventer Coop Supermarkt Molenweg 1 7396 AA Terwolde Dorpshuis ‘t Trefpunt Molenweg 53 7213 XD Gorssel Bibliotheek Gorrsel Hoofdstraat 45 7213 CR Gorssel Bibliotheek Keijzerslanden Graaf Florisstraat 3 7415 LK Deventer Bibliotheek Colmschate Flora 259, Colmschate 7422 LP Deventer Jumbo Hans Kok Flora 2, Colmschate 7422 LL Deventer Roemar koffie Walstraat 45 7411 GJ Deventer Readshop Dreiumme Dreiumme 55 7232 CN Warnsveld Gemeentehuis Zutphen ‘s-Gravenhof 2 7201 DN Zutphen VVV kantoor Zutphen - TIP Houtmarkt 75 7201 KL Zutphen Stichting Sutfene Coehoornsingel 3 7201 AA Zutphen Wijkcentrum Waterkracht Ruys de Beerenbrouckstr. 106. 7204 MR Zutphen Gelre Ziekenhuis Den Elterweg 77 7207 AE Zutphen Rodi Rotatiedruk werkt milieuvriendelijk en verantwoord. Waterless Printing, ISO 14001 Grafimedia en KVGO. Dit krantenproduct is geproduceerd door Rodi Rotatiedruk onder gecontroleerde omstandigheden conform ISO 14001 Grafimedia getoetst door de SCGM, Certificaatnummer SCGM-MZ:2011.01.02
Niets uit deze uitgave mag overgenomen worden, zonder toestemming van de uitgever. In verband met de eisen die recent zijn gesteld door de General Data Protection Regulation (GDPR), willen wij u wijzen op onze privacyverklaring die u kunt vinden op de site: www.stedendriehoek.nl/privacybeleidvan-uitgeverij-stedendriehoek.
ingezonden persberichten en foto’s wordt verwacht dat rekening is gehouden met ons privacybeleid en de foto’s rechtenvrij zijn.
Bij
jes
417 2734 63 9256 56189 6472 49 1978 512 2791 8465 16 2189 256 8467 67 3972 2435
Go Ahead Eagles wint nipt van RKC en blijft zesde

Go Ahead Eagles mocht zich zaterdagavond voor even de nummer vijf van de Eredivisie noemen. In het eigen stadion De Adelaarshorst won de ploeg van coach René Hake met 1-0 van RKC Waalwijk. Daarmee gaan de Deventenaren NEC voorbij en op dat moment ook even Ajax. Zondag wonnen de Amsterdammers echter met 2-0 van FC Utrecht en zakten de Eagles weer terug naar plaats zes.
Zonder Mats Deijl, Jamal Amofa, Bobby Adekanye en Victor Edvardsen en met een beperkte reservebank, gevuld met zeven spelers, begonnen de Eagles gehavend aan de jacht op de eerste thuisoverwinning sinds de 5-1 zege op Vitesse op 4 november 2023.
Kansenfestival
Het was een waar kansenfestival in de eerste helft. Willum Thór Willumsson ging alleen op het doel af, maar schoot, afgeleid door de terugtrekkende beweging van keeper Etienne


Vaessen, op de paal. Het was niet de enige misser van de IJslander. Even later kreeg hij de bal uit het niets in zijn voeten na een van de vele Waalwijkse fouten achterin, maar in plaats van uit te halen, legde hij de bal
af. RKC-verdediger Julian Lelieveld had het door en greep in. Uitblinker Vaessen hield in zijn 200ste wedstrijd voor RKC verschillende Eagles van scoren af, onder anderen Jakob Breum, Bas Kuipers en Finn
Foeke Komans volgt Wout Droste
Foeke Komans wordt per 1 april de nieuwe teammanager van Go Ahead Eagles. De 42-jarige Fries is de opvolger van Wout Droste, die eerder dit seizoen al aangaf uiterlijk aan het einde van de huidige voetbaljaargang te stoppen als teammanager.
“Tijdens mijn eerste levensjaren groeide ik op in een volkswijk in Sneek, maar vrij vlot ben ik vervolgens naar Leeuwarden verhuisd”, geeft Komans antwoord op de vraag waar zijn roots liggen. “Mijn vader nam me destijds altijd mee naar SC Cambuur. Zo’n stadion middenin een woonwijk doet wat met je, zoals dat ook bij Go Ahead Eagles het geval is. Jarenlang heb ik bij SC
Cambuur de wedstrijden bezocht, met als één van de hoogtepunten de promotie naar de Eredivisie in 2013. Ja, destijds maakte Wout Droste inderdaad ook deel uit van de spelersgroep van SC Cambuur.”
Band Promoveren naar de Eredivisie deed Foeke Komans ook als teammanager van de club uit de Friese

provinciehoofdstad, die in 2021 kampioen werd van de Keuken Kampioen Divisie. “In 2017 werd ik er op geattendeerd dat er in de jeugdopleiding van SC Cambuur nog gezocht werd naar een

Stokkers. In totaal verrichte de keeper zes reddingen in de eerste helft. Aan de andere kant was het aanvankelijk iets rustiger, maar ook RKC liet zich aanvallend niet onbetuigd. Zo raakte David Min de lat en was
Chris Lokesa na een diepe bal van Vaessen dichtbij. Schamel slotoffensief Er vielen minder fouten en minder kansen te noteren in de tweede helft, maar Go Ahead sloeg in de 61ste
op als teammanager
aantal teammanagers”, geeft hij aan. “Zo ben ik als teammanager begonnen bij SC Cambuur Onder-19. Een fantastisch jaar, waarin we alle wedstrijden wonnen die we maar konden winnen: 72 punten uit 24 wedstrijden. In de zomer van 2018 werd me gevraagd of ik als teammanager aan de slag wilde gaan bij de eerste selectie, waar René Hake en Dennis van der Ree op dat moment hoofd- en assistent-trainer waren. Aangezien we destijds bij SC Cambuur twee teammanagers hadden, heb ik met Dennis ook regelmatig de video-analyse gedaan
tijdens wedstrijden. Stond ik achter de camera en was hij aan het coderen. Die periode heeft wel een band geschept.”
Drijfveer
Ook met de spelersgroep van Go Ahead Eagles wil Komans vanaf 1 april een goede band opbouwen. “Ik wil graag weten hoe het met die jongens gaat. Fysiek, maar ook wat er allemaal in hun hoofd omgaat. Niet voor niets volg ik in deeltijd een opleiding psychologie. Ik ben altijd op zoek naar de drijfveer van mensen waarom ze iets wel of
Onder-15 doet volop mee op hoogste niveau
Drie jeugdteams van de Go Ahead Eagles Voetbalacademie – Onder-18, Onder-15 en Onder-14 – slaagden er zaterdag in om een uitwedstrijd in een zege om te zetten. Onder-21 en Onder-16 daarentegen leden een competitienederlaag op het hoogste jeugdniveau. Onder-13 vertoefde in Portugal voor een internationaal toernooi, waar onder andere tegen ploegen als Manchester City O13 en Benfica O13 werd gespeeld.
Onder-15 verraste Ajax O15 op De Toekomst en won voor de tweede keer op rij een uitwedstrijd met 1-2. Waar vorige week Sparta Rotterdam O15 het haasje was, moest zaterdag Ajax O15 er aan geloven. Adnan el Boujjoufi maakte beide rood-gele treffers in de eerste helft. Na de aansluitingstreffer van de Amsterdammers hielden de mannen van coach Peter Vogel stand en klommen zo naar de vijfde plek in Divisie 1A.
Hattrick Onder-18 had cijfermatig gezien weinig moeite met zijn tegenstander. In Amsterdam werd AFC O18 met 0-3 verslagen. Cem Eroglu was de gevierde man aan Deventer zijde. Hij opende na rust de score en verdubbelde die even later ook zelf. In de blessuretijd van de wedstrijd kon hij zijn hattrick voltooien vanaf elf meter. Onder-18 staat nu op de tweede plaats in Divisie 3A met evenveel punten als

koploper NEC O18, maar met een wedstrijd meer gespeeld.
Goede zaken
Op bezoek bij FC Volendam O14 deed Onder-14 heel goede zaken door met 0-1 te zegevieren. Ekene Ani Oscar maakte het enige doelpunt
van de wedstrijd. De ploeg van Patrick Kieftenbelt staat nu in Divisie 2A op de eerste plaats, drie punten los van nummer twee FC Utrecht O14.
Eerste nederlaag Onder-16 verloor voor het eerst in de voorjaarscompe-
minuut toe. Sören Tengstedt passte heel slim in één keer door op Breum en de Deen trof het doel. Met Michiel Kramer als invaller naast Min voorin, zette RKC aan voor een schamel slotoffensief. Go Ahead-keeper Jeffrey de Lange redde knap op de lijn bij een kopbal van Min en er waren in de slotfase ook nog kansen voor de thuisploeg. Het bleef echter bij die nipte 1-0, zoals RKC de voorgaande twee wedstrijden tegen Feyenoord en Fortuna Sittard ook met die cijfers verloor.
Wedstrijdkarakteristieken
Go Ahead Eagles-RKC Waalwijk 1-0 (0-0).
62’ Jakob Breum 1-0.
Scheidsrechter: Pol van Boekel.
Gele kaart: Julian Lelieveld (RKC Waalwijk).
Go Ahead Eagles: Jeffrey de Lange; Luca Everink (73’ Pim Saathof), Gerrit Nauber, Joris Kramer, Bas Kuipers; Evert Linthorst, Enric Llansana; Søren Tengstedt (67’ Thibo Baeten), Willum Willumsson, Jakob Breum (67’ Oliver Edvardsen); Finn Stokkers (83’ Dean James).
RKC Waalwijk: Etienne Vaessen; Julian Lelieveld (46’ Juriën Gaari), Shawn Adewoye, Dario van den Buijs, Aaron Meijers (86′ Ilias Takidine); Godfried Roemeratoe, Yassin Oukili; Denilho Cleonise (75’ Filip Stevanovic), Reuven Niemeijer (75’ Michiel Kramer), Chris Lokesa (75’ Zakaria Bakkali); David Min.
juist niet doen. Als je op een goed niveau een relatie aan kunt gaan met de mensen in je directe omgeving, dan kun je daarop bouwen. Of het nu gaat om de stafleden en spelers van de eerste selectie, secretaris voetbalzaken Adrie Steenbergen, collega-teammanager Alfred Knippenberg, de medewerkers op kantoor of de dames die in de keuken van het spelershome staan. Je moet het met elkaar doen. Ik ben niet iemand die zelf per se op de voorgrond hoeft te staan. Als ik daarentegen anderen kan laten shinen, dan kan ik daar enorm van genieten.”
in het tweede bedrijf maakte Matthew Amoah junior –zoon van de gelijknamige NAC-legende – de tweede treffer voor Feyenoord O15.
Eigen doelpunt
titie. Feyenoord O16 was met 2-0 te sterk voor de equipe van coach Jip Ellenbroek, die nog wel de ranglijst aanvoert in Divisie 1A. Feyenoord O16 is wel tot één punt genaderd met nog een wedstrijd achter de hand. In de eerste helft scoorden de Rotterdammers de 1-0 en
Ook Onder-21 verloor op het hoogste niveau met 0-1 van FC Twente/Heracles O21. Het merendeel van de wedstrijd stond er 0-0 op het scorebord, maar door een ongelukkig eigen doelpunt gingen de Tukkers er met de volle buit ervandoor.
Voor Onder-21 was het de vierde achtereenvolgende nederlaag en daardoor blijft het onderin de ranglijst van Divisie 1A bivakkeren. Volgende week staat het cruciale duel met nummer 7 NEC O21 op het programma.
Go Ahead Eagles 15
thea
ter han
zehof
Bestel je tickets op
www.hanzehof.nl
vr.08.03 muziek
Echoes of the Earth, Sea and Mountains M’ANAM
20.00 uur
Buitensociëteit

wo.13.03 toneel
Anne Wil Blankers, Henriëtte Tol & Renée Fokker
Fokker Blankers Tol
20.15 uur
Theaterzaal
vr.22.03 concert/klassiek
Untitled 3 Lavinia Meijer
20.00 uur
Buitensociëteit

zo.31.03 familie/toneel
Over jongeren met geldproblemen Cashflow (14+)
15.00 uur
Buitensociëteit
do.04.04
Slachthuis Vijf van Theater Rotterdam Minicollege over Kurt Vonnegut door Gilles Groot
20.00 uur
Studio
theatercollege
vr.15.03 muziek
Tour-ja of Tour-nee

Roberto Jacketti & The Scooters
20.15 uur
Theaterzaal

za.16.03 concert
Dweilorkest 't Spul(t) & Friends Vrienden aan de IJssel
20.00 uur
Buitensociëteit


do.11.04 concert
From Ireland With Love The Celtic Tenors
20.00 uur
Buitensociëteit

Ook te zien dit seizoen:

The Music of Enrico Pieranunzi, Gerlof Meijer, Boer Boris is de baas, Kinan Azmeh, Eric Vloeimans & Jeroen van Vliet, Dominc Seldis, Koninklijk Zutphens Mannenkoor, Jim Deddes, Je Anne, Pianostemmen, Bumba en vele anderen.
Dit is een selectie van onze voorstellingen. Kijk voor het volledige programma op www.hanzehof.nl